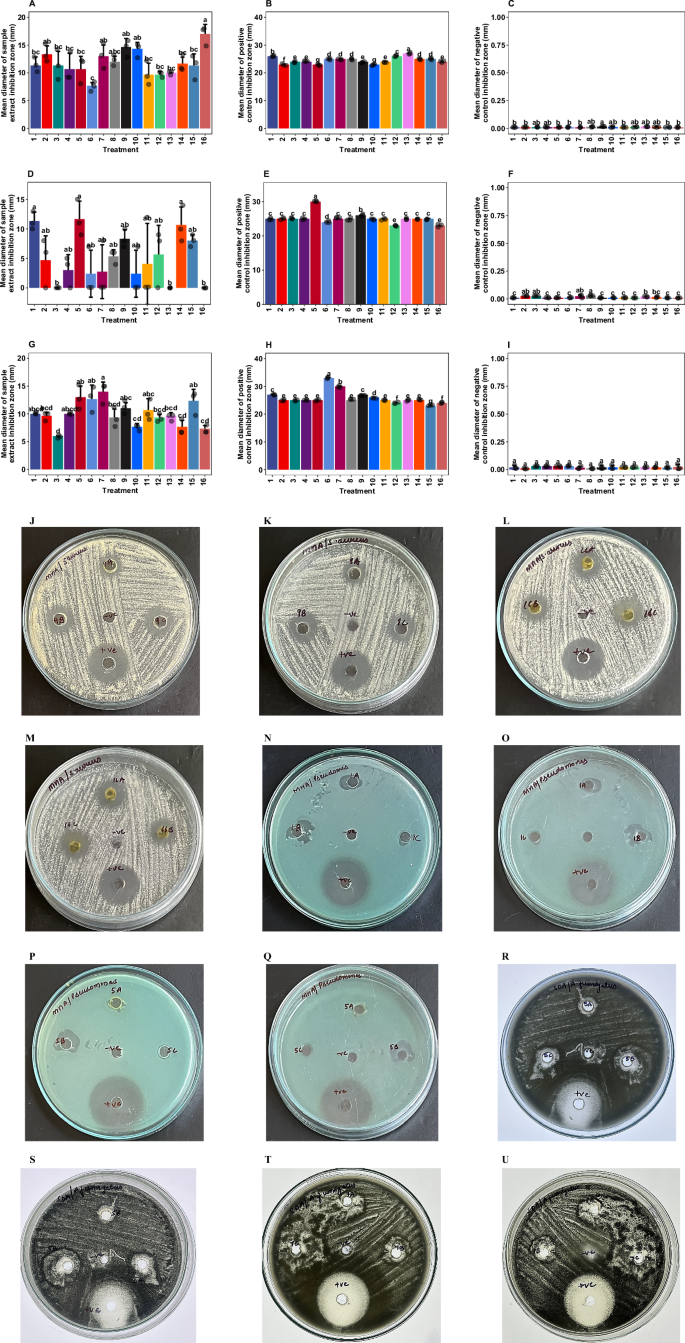
Fig. 6: Antimicrobial and antifungal activity of A. annua callus extracts.

Abstract
Artemisia annua L. callus cultures are valuable systems for producing the antimalarial artemisinin, yet enhancing yields via elicitation is challenging. This study delineates how combining plant growth regulators (PGRs) and silver nitrate (AgNO3) affects biomass, artemisinin biosynthesis, antioxidant responses, and bioactivity. A. annua calli were treated with PGRs (BAP, NAA, 2,4-D) and elicited with AgNO3 to assess resulting metabolic and bioactive profiles. While 1 mg/L AgNO3 in media containing 5 mg/L BAP and 1 mg/L NAA augmented fresh and dry biomass by 182% and 227%, it decoupled growth from secondary metabolism; artemisinin content reached only 0.83-fold that of wild plants. Notably, Silver ions showed context-specific roles, attenuating oxidative stress under 2,4-D-induced high stress but exacerbating it under NAA-mediated low stress. Extracts demonstrated differential antimicrobial activity, with the most significant inhibition observed against Staphylococcus aureus. Specific elicitor combinations drive metabolic trade-offs in A. annua callus, providing a framework to optimize the controlled biosynthesis of therapeutic compounds.

Similar content being viewed by others
Introduction
Artemisia annua L., a fast-growing member of the Asteraceae family, is the sole commercial source of artemisinin—a sesquiterpene lactone that transformed malaria therapy following its isolation in 1972. Artemisinin’s potent activity against Plasmodium falciparum, including drug-resistant strains, underpins WHO-recommended artemisinin-based combination therapies (ACTs)1,2,3,4,5,6. Its antiparasitic effect stems from heme-activated cleavage of an endoperoxide bridge, generating cytotoxic radicals that compromise parasite viability. Despite its therapeutic value, the artemisinin content in A. annua remains low (0.1–1.5% dry weight), being largely restricted to glandular secretory trichomes (GSTs), which poses a major limitation to scalable production7. Coupled with the plant’s 6-month growth cycle and labor-intensive extraction, this bottleneck constrains ACT access in endemic regions. In sub-Saharan Africa, fewer than 60% of febrile children receive appropriate treatment8. Tea infusions of A. annua—though culturally accepted and enriched with synergistic flavonoids—deliver subtherapeutic artemisinin doses (~40.2 mg/day), due to inconsistent phytochemical profiles, low aqueous solubility, and variable absorption9. Beyond artemisinin, the plant yields over 200 metabolites with antioxidant, antimicrobial, and metabolic activities, some of which may enhance artemisinin bioavailability by modulating cytochrome P450 enzymes10.
Plants have evolved intricate defense mechanisms to cope with a wide range of biotic and abiotic stresses, including fluctuations in temperature, drought, salinity, and heavy metal toxicity11. Central to these adaptive responses is ascorbate peroxidase (APX), a key enzyme in the detoxification of hydrogen peroxide (H₂O₂), a major reactive oxygen species (ROS)11,12. As a core component of the highly conserved ascorbate-glutathione cycle, APX serves as a sensitive and rapid indicator of oxidative stress, reflecting the cell’s effort to preserve redox homeostasis under adverse conditions.
This enzymatic activity functions within a broader antioxidant defense network (Fig. 1), which is closely integrated with the biosynthesis of secondary metabolites—diverse bioactive compounds such as alkaloids, terpenoids, and phenolics that play essential roles in stress resilience and have significant pharmaceutical and industrial applications (e.g., artemisinin, vincristine, and antioxidant flavonoids)13. Environmental cues elicit remarkable biochemical plasticity, orchestrating the production of secondary metabolites through multi-layered regulatory circuits that involve elicitors, transcription factors, epigenetic modulators, and enzymatic cascades12,14,15,16.
Abiotic and biotic stressors trigger the overaccumulation of ROS, such as superoxide (O₂−) and hydrogen peroxide (H₂O₂), primarily in organelles like chloroplasts, mitochondria, and peroxisomes. While low levels of ROS function as critical signaling molecules, excessive accumulation leads to oxidative stress, causing damage to vital cellular components, including lipids, proteins, and nucleic acids183,207. To maintain redox homeostasis, plants employ a sophisticated defense system comprising both non-enzymatic antioxidants (e.g., ascorbate, AsA; glutathione, GSH) and enzymatic scavengers. This network’s primary enzymes include superoxide dismutase (SOD), which converts O₂− to H₂O₂, alongside catalase (CAT) and various peroxidases that detoxify H₂O₂12,14,15. Among these, ascorbate peroxidase (APX; EC 1.11.1.11) is a central component of the ascorbate-glutathione cycle and a critical regulator of H₂O₂ concentrations, and was therefore selected as a key biomarker for oxidative stress in this study11. The coordinated action of this network enables plants to mitigate oxidative damage while utilizing ROS for stress signaling and physiological adaptation17,189,208. APX ascorbate peroxidase, AsA ascorbate, CAT catalase, DHA dehydroascorbate, DHAR dehydroascorbate reductase, GPX glutathione peroxidase, GSH reduced glutathione, GST glutathione S-transferase, H₂O₂ hydrogen peroxide, MDHA monodehydroascorbate, MDHAR monodehydroascorbate reductase, NADPH nicotinamide adenine dinucleotide phosphate, O₂•− superoxide anion, POX peroxidases, PRX peroxiredoxins, SOD superoxide dismutase, TRX thioredoxin. Key: Red dotted arrows represent ROS production, solid red arrows indicate causal relationships, black dotted arrows depict regulation and mitigation pathways of ROS.
Unlike other ROS-scavenging enzymes, such as catalase, APX exhibits dynamic responsiveness across a broad spectrum of environmental stressors, making it a particularly versatile biomarker for redox perturbation17. Quantification of APX activity thus provides a robust and real-time measure of oxidative stress, linking cellular redox dynamics with larger-scale metabolic and adaptive responses.
Artemisinin biosynthesis in A. annua is governed by a complex network of transcription factors (TFs) and phytohormonal signals18. The identification of AaWRKY1 as a positive regulator of biosynthetic genes marked a key breakthrough, followed by the discovery of additional TFs—AaERF1/2, AaORA, AaMYC2, AaTCP14/15, AaSPL2, and others—that integrate jasmonate (JA), abscisic acid (ABA), gibberellin (GA), and salicylic acid (SA) signaling18,19. These TFs, spanning families such as WRKY, AP2/ERF, bZIP, MYB, and NAC, orchestrate the transcriptional activation of core pathway genes18,19. In contrast, ethylene functions as a negative regulator. Through AaEIN3, it represses ADS, DBR2, CYP71AV1, and AaORA, while promoting senescence20. This antagonistic role highlights the significance of hormonal crosstalk in modulating pathway output. Biosynthesis is also developmentally staged. Young leaves show peak expression of biosynthetic genes and dihydroartemisinic acid (DHAA) accumulation, while mature leaves exhibit a decline20,21. Paradoxically, senescent leaves show a resurgence in artemisinin levels, now attributed to singlet oxygen (1O₂) bursts that both signal gene reactivation and drive DHAA oxidation22. Environmental cues like chilling similarly enhance 1O₂ signaling, linking oxidative stress to elevated production22. Together, these findings reveal a multi-layered regulatory system encompassing transcriptional, hormonal, oxidative, and developmental controls. The persistent dominance of DBR2 expression and the signaling role of 1O₂ present new targets for metabolic engineering and elicitor strategies22. To overcome constraints of low yields, climate sensitivity, and emerging resistance, integrative strategies are advancing. These include: (1) genome editing and pathway engineering to boost MVA/MEP flux; (2) standardized cultivation systems for scalable production; and (3) novel delivery formats such as functional foods. These efforts, coupled with innovations in vector control and antimalarial therapy, are critical to securing sustainable artemisinin supply and therapeutic efficacy.
Conventional extraction of high-value phytochemicals from wild or cultivated plants is increasingly unsustainable due to slow growth, ecological overharvesting, and environmental constraints13. In vitro culture systems offer a scalable and controllable alternative, decoupling production from geographic and seasonal limitations. Elicitation has emerged as a potent strategy to stimulate secondary metabolite biosynthesis under laboratory conditions. Abiotic elicitors such as CuSO₄ and HgCl₂ mimic stress signals, activating transcriptional networks linked to specialized metabolism. In Bellis perennis L., CuSO₄ application significantly enhances flavonoid accumulation, including luteolin and apigenin23. Plant tissue culture platforms, such as callus and cell suspension cultures, offer controlled, reproducible environments for the high-yield production of specialized metabolites16. In A. annua, these in vitro systems have been instrumental in scaling up artemisinin biosynthesis through targeted metabolic engineering, such as the overexpression of key pathway genes and enhancement of precursor flux18. By decoupling metabolite production from environmental and agronomic variability, these approaches reduce dependency on field-grown plants and stabilize supply chains for pharmaceutical applications13,24. This integration of synthetic biology with plant culture methodologies provides a strategic solution to persistent bottlenecks in natural product-based drug development, enabling sustainable, year-round production independent of ecological constraints.
Silver ions (Ag⁺, as AgNO₃) and silver nanoparticles (AgNPs) are widely utilized across sectors due to their ability to elicit stress responses and modulate secondary metabolism in plants, yet both forms exert complex, often overlapping, phytotoxic and stress-eliciting effects on plants25,26,27,28. Although AgNPs are often credited for superior physicochemical properties—including controlled ion release, size-dependent uptake, and modulation of gene expression—evidence suggests silver ions (Ag⁺), particularly from AgNO₃, may provoke more consistent and pronounced metabolic responses25,27. Notably, Kruszka et al. demonstrated that AgNO₃ induced a more consistent and potent accumulation of defense-related metabolites, such as camalexin and other secondary metabolites in Arabidopsis thaliana compared to AgNPs, attributing this to its potent elicitor activity, possibly via ethylene suppression, altered nitrogen metabolism, and jasmonic acid (JA) and salicylic acid (SA) signaling25,27. While AgNPs also triggered notable metabolic shifts, these responses were more variable, highly size- and concentration-dependent, and influenced by their tendency to aggregate, particularly in aqueous media27. Both Ag forms accumulated in plant tissues and deposited predominantly as elemental silver, with AgNO₃ and 40 nm AgNPs showing the highest uptake27. These findings support the view that AgNPs may exert their effects largely through controlled ion release, albeit with added complexities due to nanoparticle-specific behaviors. Similarly, Iqbal et al.29 reported that AgNO₃ was more phytotoxic than AgNPs in sugarcane callus cultures, inducing higher phenolic and flavonoid levels, while AgNPs favored protein synthesis and stress-induced proline accumulation. Importantly, both forms enhanced antioxidant activity and biomass at lower concentrations. In contrast, studies in Caralluma tuberculata and Aerva sanguinolenta emphasized AgNPs’ value in stimulating callus proliferation and secondary metabolite production when synergized with plant growth regulators or salicylic acid30,31. Meanwhile, Zeinab Bakr et al. found no significant difference in oxidative and genotoxic impacts between AgNPs and AgNO₃ in land slugs, suggesting comparable toxicity across taxa32. Collectively, these findings underscore that both AgNO₃ and AgNPs can induce stress-related responses, but their effects are highly context-dependent—shaped by concentration, particle size, plant species, and application method—necessitating tailored approaches for their safe and effective use in plant systems.
Silver nitrate (AgNO₃) has been widely employed as a precursor for silver nanoparticle (AgNP) synthesis across diverse applications (Supplementary Table 1). In prior studies, pre-formed AgNPs have served as abiotic elicitors to induce oxidative stress and enhance metabolite production—such as artemisinin and flavonoids—in A. annua33,34. Alternatively, Artemisia extracts have been used for green synthesis of AgNPs from AgNO₃, yielding stable nanoparticles (5–50 nm) with potent antimicrobial, catalytic, and biomedical utility35,36,37,38,39. AgNPs demonstrated efficacy against pathogens such as Candida, MRSA, and Phytophthora via membrane disruption and oxidative damage40,41,42,43. In contrast, direct use of unreacted AgNO₃ has been rare, despite its potential as an ethylene inhibitor and oxidative stress inducer. Few studies have explored AgNO₃‘s direct effects on A. annua44,45. Lei et al. demonstrated that its application enhances shoot morphogenesis in A. annua leaf explants by suppressing ethylene biosynthesis, thereby promoting shoot regeneration and elongation. In parallel, Saghizadeh et al. showed that it induces phenolic accumulation and upregulates antioxidant enzymes such as glutathione S-transferase (GST) and phenylalanine ammonia-lyase (PAL) in shoot cultures, although artemisinin biosynthesis remained unaltered—unlike the response observed with copper treatment.
The optimization of secondary metabolite biosynthesis in medicinal plants hinges on a mechanistic understanding of cellular regulation under stress. In A. annua, undifferentiated callus cultures serve as a tractable system to dissect how external stimuli modulate metabolic pathways. Plant growth regulators (PGRs) and abiotic elicitors offer complementary strategies to enhance secondary metabolite production. By modulating auxin–cytokinin ratios, PGRs directly influence the trade-off between cell proliferation and specialized metabolism. Meanwhile, abiotic elicitors—including heavy metals—mimic environmental pressures to activate stress-responsive transcriptional programs linked to metabolite biosynthesis. These elicitors serve as powerful tools to probe the signaling networks governing secondary metabolism, providing a framework to optimize yields through environmental mimicry.
Silver nitrate (AgNO₃) is a uniquely potent modulator in this context, known to function through at least two distinct mechanisms. As a heavy metal, it acts as a general stressor, inducing the production of reactive oxygen species (ROS) that can trigger broad defense responses. Simultaneously, silver ions (Ag⁺) are specific and potent inhibitors of the ethylene signaling pathway. This is particularly relevant for artemisinin biosynthesis, as ethylene has been identified as a negative regulator of the pathway’s key genes (Fig. 2). Despite the known effects of individual PGRs or elicitors, research that systematically investigates the synergistic and antagonistic interactions between different PGR-induced physiological states and a specific dual-action modulator like AgNO₃ remains limited. Such an approach is critical for understanding how to uncouple growth from defense to maximize the yield of target compounds.
The diagram illustrates the hypothesized mechanism by which silver ions (Ag⁺), applied as silver nitrate (AgNO₃), influence artemisinin biosynthesis in A. annua callus. Ag⁺ acts via two distinct pathways. (1) Ethylene signaling inhibition: Ag⁺ binds to and inactivates ethylene receptors (e.g., ETR1/2, ERS1/2, EIN4), which stabilizes the key transcription factors Ethylene-insensitive 3/ethylene-insensitive 3-like (EIN3/EIL). In A. annua, this action is proposed to de-repress downstream transcription factors (ERFs, notably AaEIN3) that negatively regulate artemisinin biosynthetic genes (ADS, CYP71AV1, DBR2), thereby modulating pathway flux. (2) Abiotic stress induction: as a heavy metal elicitor, Ag⁺ also induces the production of reactive oxygen species (ROS), triggering a cellular stress response. This dual action collectively shapes the trade-off between growth, the antioxidant defense system (e.g., ascorbate peroxidase, APX, activity), and the production of specialized metabolites like artemisinin, ultimately determining the callus’s overall bioactive profile. Key: dark solid arrows represent activation, stimulation, or progression within a biochemical or signaling pathway. Red solid arrows indicate inhibitory effects, while red “×” symbols denote the complete abrogation or switching off of a signaling route. Red brackets signify collective downregulation of grouped components. Yellow dotted arrows highlight regulatory processes occurring within the nucleus. A question mark (“?”) denotes mechanisms that remain unclear or not fully elucidated. Red dotted arrows illustrate a direct causal relationship, whereas dark dotted arrows indicate a sequence involving multiple intermediary steps leading to a specific outcome. MVA mevalonic acid G3P glyceraldehyde 3-phosphate, MEP 2-C-methyl-D-erythritol-4-phosphate IPP isopentenyl pyrophosphate, IDI IPP isomerase, DMAPP dimethylallyl pyrophosphate, ADS amorphadiene synthase, CPR cytochrome P450 reductase, CYP71AV1 cytochrome P450 71AV1, ADH1 artemisinic alcohol dehydrogenase 1, ALDH1 artemisinic aldehyde dehydrogenase 1, ETC electron transport chain, H₂O₂ hydrogen peroxide, NADPH nicotinamide adenine dinucleotide phosphate, O₂•− superoxide anion, 1O₂ singlet oxygen, OH• hydroxyl radical, ROS reactive oxygen species, SOD superoxide dismutase, MET L-methionine, SAM S-adenosyl-L-methionine, ACC 1-amino-1-carboxycyclopropane, ACS ACC synthase, ACO ACC oxidase, EIN, ethylene insensitive, ETR1/2 ethylene receptor 1/2, ERS1/2, ethylene response sensor 1/2, CTR1 constitutive triple response 1, ERFs ethylene-responsive factors, EBF1/2 EIN3-binding F-box protein 1/2.
Given this background, the present study was designed to test the central hypothesis that inhibiting ethylene signaling with AgNO₃, in concert with specific PGRs, would fundamentally modulate the stress physiology and metabolic trade-offs in A. annua callus cultures. The primary objectives were to: (1) establish an efficient callus induction system using various combinations of auxins and cytokinins to create distinct baseline physiological states; (2) comprehensively evaluate the effects of AgNO₃ as an elicitor on callus morphology, biomass accumulation, artemisinin content, and antioxidant activity, using APX as a key stress biomarker; and (3) assess the broader therapeutic potential of the resulting extracts through phytochemical profiling and antimicrobial assays. This work provides the first systematic comparison of AgNO₃'s effects across different hormonal backgrounds, addressing a critical gap in elicitation strategies for this vital medicinal plant, and proposes mechanistic insights into elicitor-responsive metabolism.
Results
Callus induction from A. annua leaf explants is highly dependent on PGR composition
To evaluate the influence of various PGRs on callus induction from A. annua leaf explants, thirteen media formulations with different PGR combinations were tested. After 6 weeks, only four treatments successfully induced callus formation (Table 1; Fig. 3; Supplementary Data Figs. 4 and 5). The highest callus proliferation intensity was observed with 5 mg/L BAP + 1 mg/L NAA (G), followed by 1 mg/L BAP + 1 mg/L 2,4-D (F), 1 mg/L KN + 1 mg/L NAA (L), and 0.1 mg/L BAP + 1 mg/L 2,4-D. Callus from treatment G appeared green-pale yellow and non-friable; F-induced callus was pale yellow-green and non-friable, while treatments L and the latter produced non-friable, pale yellow-brown callus (Fig. 3). The remaining nine treatments showed no callus response, except for 5 mg/L BAP + 1 mg/L 2,4-D and 1 mg/L KN + 1 mg/L 2,4-D, which prompted direct shoot formation via organogenesis.
G (5 mg/L BAP + 1 mg/L NAA), L (1 mg/L KN + 1 mg/L NAA), and F (1 mg/L BAP + 1 mg/L 2,4-D).
A–D Quantitative analysis of biomass and crude extract yield from A. annua callus cultures after 6 weeks of treatment. Panels show mean fresh weight (A), mean dry weight (B), mean dry weight of the crude extract (C), and the corresponding percentage yield of the extract (D). E–S Representative images showing the morphology of callus cultures under different treatment conditions (Supplementary Table 3). T A six-week-old wild A. annua plant, the source of the leaf explants. Treatment details (1–16) are as follows: Treatment 1: 1 mg/L BAP + 1 mg/L 2,4-D; Treatment 2: 5 mg/L BAP + 1 mg/L NAA; Treatment 3: 1 mg/L KN + 1 mg/L NAA; Treatment 4: 1 mg/L BAP + 1 mg/L 2,4-D + 0.5 mg/L AgNO3; Treatment 5: 1 mg/L BAP + 1 mg/L 2,4-D + 1.0 mg/L AgNO3; Treatment 6: 1 mg/L BAP + 1 mg/L 2,4-D + 2.0 mg/L AgNO3; Treatment 7: 5 mg/L BAP + 1 mg/L NAA + 0.5 mg/L AgNO3; Treatment 8: 5 mg/L BAP + 1 mg/L NAA + 1.0 mg/L AgNO3; Treatment 9: 5 mg/L BAP + 1 mg/L NAA + 2.0 mg/L AgNO3; Treatment 10: 1 mg/L KN + 1 mg/L NAA + 0.5 mg/L AgNO3; Treatment 11: 1 mg/L KN + 1 mg/L NAA + 1.0 mg/L AgNO3; Treatment 12: 1 mg/L KN + 1 mg/L NAA + 2.0 mg/L AgNO3; Treatment 13: 1 mg/L BAP + 1 mg/L 2,4-D + 1.0 mg/L AgNO3; Treatment 14: 5 mg/L BAP + 1 mg/L NAA + 1.0 mg/L AgNO3; and Treatment 15: 1 mg/L KN + 1 mg/L NAA + 1.0 mg/L AgNO3; and Treatment 16: Wild A. annua leaf extract (six-week-old; 3rd−5th node). Data are presented as mean ± standard error (SE), and bars with different letters indicate statistically significant differences according to Tukey’s HSD test (p ≤ 0.05).
A, B Quantification of artemisinin content across all sixteen treatments, showing the mean retention time (A) and mean concentration (B). C–K Representative HPLC chromatograms showing the alignment of the artemisinin standard (green line) with the sample extract (blue line). The detected artemisinin peak in the sample is highlighted (red line). Panels display triplicate results from the wild-type leaf with the highest detected artemisinin content (Sample 16, 588 µg/mL) (C–E), the most productive callus culture (Sample 2, 487 µg/mL) (F–H), and a non-producing callus culture (Sample 7, 0 µg/mL) (I–K). Treatment details (1–16) are as follows: Treatment 1: 1 mg/L BAP + 1 mg/L 2,4-D; Treatment 2: 5 mg/L BAP + 1 mg/L NAA; Treatment 3: 1 mg/L KN + 1 mg/L NAA; Treatment 4: 1 mg/L BAP + 1 mg/L 2,4-D + 0.5 mg/L AgNO3; Treatment 5: 1 mg/L BAP + 1 mg/L 2,4-D + 1.0 mg/L AgNO3; Treatment 6: 1 mg/L BAP + 1 mg/L 2,4-D + 2.0 mg/L AgNO3; Treatment 7: 5 mg/L BAP + 1 mg/L NAA + 0.5 mg/L AgNO3; Treatment 8: 5 mg/L BAP + 1 mg/L NAA + 1.0 mg/L AgNO3; Treatment 9: 5 mg/L BAP + 1 mg/L NAA + 2.0 mg/L AgNO3; Treatment 10: 1 mg/L KN + 1 mg/L NAA + 0.5 mg/L AgNO3; Treatment 11: 1 mg/L KN + 1 mg/L NAA + 1.0 mg/L AgNO3; Treatment 12: 1 mg/L KN + 1 mg/L NAA + 2.0 mg/L AgNO3; Treatment 13: 1 mg/L BAP + 1 mg/L 2,4-D + 1.0 mg/L AgNO3; Treatment 14: 5 mg/L BAP + 1 mg/L NAA + 1.0 mg/L AgNO3; and Treatment 15: 1 mg/L KN + 1 mg/L NAA + 1.0 mg/L AgNO3; and Treatment 16: Wild A. annua leaf extract (six-week-old; 3rd–5th node). Data are presented as mean ± standard error (SE), and bars with different letters indicate statistically significant differences according to Tukey’s HSD test (p ≤ 0.05).
AgNO₃ elicitation alters callus morphology in A. annua cultures
To assess the impact of AgNO₃ elicitation on A. annua callus cultures, three experimental groups were established using treatments F, G, and L as the base: (i) Group 1: callus was induced using F, G, and L in triplicate; (ii) Group 2: calli from Group 1 were subcultured on MS medium with corresponding PGRs and AgNO₃ at 0.5, 1.0, or 2.0 mg/L; (iii) Group 3: fresh leaf explants were cultured on MS medium with corresponding PGRs and 1.0 mg/L AgNO₃.
As shown in Table 2, all treatments across the groups either supported the maintenance of callus subcultures (Groups 1 and 2) or promoted callus induction (Group 3). Calli ranged in color from green to dark brown but remained non-friable across treatments. F-derived calli—with or without AgNO₃ (treatments 1, 4–6, 13)—were typically pale green to green with less browning. In contrast, G- and L-derived calli appeared pale green to brown without AgNO₃ (treatments 2–3), and pale brownish yellow to dark brown when elicited (treatments 7–12, 14–15) (Fig. 4E-S).
Biomass accumulation and extract yields vary significantly across treatments
After 6 weeks of culture, samples 1–16 were obtained in response to the respective treatments (Fig. 4E–S). All fresh samples were initially weighed, and their fresh weights were recorded. Significant variation in fresh weight was observed within and across treatments (Fig. 4A). Treatment 14 yielded the highest mean fresh weight (3.08 g), significantly exceeding treatments 1 and 2 (p < 0.0165) (Supplementary Tables 12 and 13). Treatment 2 produced the second-highest mean fresh weight (2.72 g), followed by treatments 9 (2.26 g), 8 (2.24 g), and 6 (2.18 g). Treatments 1 and 11 resulted in the lowest fresh weights (1.09 g), though these were not significantly different from other treatments (p > 0.05).
For dry weight (Fig. 4B), treatment 14 again produced the highest mean value (0.324 g), significantly surpassing treatments 1 (0.0992 g), 3 (0.130 g), 5 (0.133 g), 11 (0.142 g), 13 (0.148 g), and 15 (0.152 g) (p < 0.03363). Treatments 12, 9, and 10 followed with dry weights of 0.220 g, 0.205 g, and 0.202 g, respectively. Treatment 1 had the lowest dry weight, though this was not statistically different from the majority of other treatments (p > 0.05).
Crude extract yields (Fig. 4C) mirrored these trends. Treatment 14 produced the highest mean dry extract weight (0.0457 g), significantly higher than treatments 5 (0.0105 g) and 11 (0.00927 g) (p < 0.001). Treatment 1 followed with 0.0380 g, then treatments 15 (0.0306 g), 12 (0.0286 g), 13 (0.0242 g), and 9 (0.0209 g), though differences among these were not statistically significant (p > 0.05).
In terms of percentage yield (Fig. 4D), treatment 1 yielded the highest mean percentage (0.653%), significantly higher than treatments 4–11 (p < 0.0031). Treatment 15 followed (0.447%), then treatments 13 (0.344%) and 12 (0.315%), with no significant differences between these and other treatments (p > 0.05).
For Sample 16 (wild A. annua leaves), the mean fresh weight (~1.50 g) was not significantly different from the callus samples (p > 0.05; Fig. 4A). However, its mean dry weight differed significantly from most treatments (p < 0.05), except for Treatments 6, 9, 10, 12, and 14, which showed no statistically significant differences (Fig. 4B). The crude extract dry weight did not differ significantly (p > 0.05) from any callus-derived samples (Fig. 4C). Similarly, extract yield was comparable across treatments (p > 0.05), except for Treatment 1, which exhibited a significantly different yield (p < 0.05; Fig. 4D).
Quantification of artemisinin via validated HPLC calibration
To ensure analytical accuracy and reproducibility, all standard and sample solutions were injected in duplicate (20 μL). Instrument precision was confirmed through five replicate injections of a 900 μg/mL mid-range standard, yielding relative standard deviations (RSD) below 2.0% for both retention time and peak area. A validated three-point calibration curve (800–1000 μg/mL) was constructed by plotting peak area (measured at 210 nm) against artemisinin concentration (Supplementary Fig. 11), demonstrating excellent linearity (R² > 0.99). Key validation parameters included:
-
Correlation coefficient: R² > 0.9935
-
Intercept: 476.594 (95% CI)
-
Slope: 4.11125 × 10−⁵
Artemisinin concentrations in samples were determined using the regression equation: y = 4.11125 × 10−⁵x + 476.594,
where y is the artemisinin concentration (μg/mL) and x is the peak area (mAU*s). The narrow calibration range was appropriate for the anticipated sample concentrations and encompassed all measured values.
After 6 weeks of culture, crude extracts from samples 1–15 were prepared for artemisinin quantification, while fresh mature leaves from the 3rd to 5th nodal positions of the six-week-old wild A. annua plant (sample 16) were harvested for comparative analysis. Artemisinin concentrations were measured using high-performance liquid chromatography (HPLC) across all samples (1–16). The highest mean concentration was recorded in the wild leaf sample (sample 16) at 588 µg/mL, which was significantly higher than that of all cultured samples (1–15) (p < 0.02679) (Fig. 5A, Supplementary Fig. 12). The next highest concentrations were observed in sample 2 (487 µg/mL), followed closely by samples 15, 14, and 4 (each 480 µg/mL) (Supplementary Table 14). In contrast, artemisinin was either absent or present at negligible levels in sample 7 (Fig. 5A, C). While the mean retention time for sample seven differed significantly from all other samples (p < 0.03346), no significant differences in retention time were observed among the remaining samples (p > 0.05) (Fig. 5B).
Evaluation of antimicrobial activity of crude extracts
The antimicrobial activity of all sixteen crude sample extracts was assessed against Staphylococcus aureus (ATCC 25923), Pseudomonas aeruginosa (ATCC 27853), and Aspergillus fumigatus using the well-diffusion method. The extracts exhibited highly variable, pathogen-dependent bioactivity.
A pronounced antibacterial effect was observed against S. aureus. The wild leaf extract (sample 16) produced the highest mean inhibition zone (17 mm), a value significantly greater than most callus-derived extracts (p < 0.0001). Several calli extracts also showed notable activity, including sample 9 (14.7 mm) and sample 10 (14.3 mm), which were not statistically different from other active samples such as 2 (13.3 mm), 7 (13 mm), and 8 (12 mm) (p > 0.05) (Fig. 6A; Supplementary Fig. 14). For context, positive and negative controls produced inhibition zones of 23–27 mm and 0.01–0.015 mm, respectively (Fig. 6B, C, J–M).
A, D, G Zone of inhibition (ZOI) results from well-diffusion assays against A Staphylococcus aureus, D Pseudomonas aeruginosa, and G Aspergillus fumigatus. B, E, H Corresponding positive controls using standard inhibitors. C, F, I Corresponding negative controls (hexane). J–U Representative images of the well-diffusion assays for the most active extracts against each pathogen, presented as paired plate views (agar side followed by lid side): J–M Extracts 9 and 16 against S. aureus; N–Q Extracts 1 and 5 against P. aeruginosa; and R–U Extracts 5 and 7 against A. fumigatus. Treatment details (1–16) are as follows: Treatment 1: 1 mg/L BAP + 1 mg/L 2,4-D; Treatment 2: 5 mg/L BAP + 1 mg/L NAA; Treatment 3: 1 mg/L KN + 1 mg/L NAA; Treatment 4: 1 mg/L BAP + 1 mg/L 2,4-D + 0.5 mg/L AgNO3; Treatment 5: 1 mg/L BAP + 1 mg/L 2,4-D + 1.0 mg/L AgNO3; Treatment 6: 1 mg/L BAP + 1 mg/L 2,4-D + 2.0 mg/L AgNO3; Treatment 7: 5 mg/L BAP + 1 mg/L NAA + 0.5 mg/L AgNO3; Treatment 8: 5 mg/L BAP + 1 mg/L NAA + 1.0 mg/L AgNO3; Treatment 9: 5 mg/L BAP + 1 mg/L NAA + 2.0 mg/L AgNO3; Treatment 10: 1 mg/L KN + 1 mg/L NAA + 0.5 mg/L AgNO3; Treatment 11: 1 mg/L KN + 1 mg/L NAA + 1.0 mg/L AgNO3; Treatment 12: 1 mg/L KN + 1 mg/L NAA + 2.0 mg/L AgNO3; Treatment 13: 1 mg/L BAP + 1 mg/L 2,4-D + 1.0 mg/L AgNO3; Treatment 14: 5 mg/L BAP + 1 mg/L NAA + 1.0 mg/L AgNO3; and Treatment 15: 1 mg/L KN + 1 mg/L NAA + 1.0 mg/L AgNO3; and Treatment 16: Wild A. annua leaf extract (six-week-old; 3rd–5th node). Data are presented as mean ± standard error (SE), and bars with different letters indicate statistically significant differences according to Tukey’s HSD test (p ≤ 0.05).
In contrast, extracts exhibited only modest inhibitory activity against P. aeruginosa. The largest mean inhibition zone was recorded for sample 5 (11.7 mm), followed by sample 1 (11.3 mm) and sample 14 (10.7 mm). While biologically modest compared to the positive control (23–30 mm), the activity of these top samples was statistically significant when compared to treatments showing no inhibition, such as samples 3, 13, and 16 (each 0.01 mm; p < 0.005856) (Fig. 6D, E, N–Q and Supplementary Fig. 15).
The extracts produced moderate antifungal effects against A. fumigatus. Sample 7 exhibited the highest inhibition zone (14 mm), which was significantly greater than most other samples (p < 0.000711). However, its activity was not statistically different from other moderately effective extracts, including sample 5 (13 mm), sample 6 (12.7 mm), and sample 15 (12.3 mm) (p > 0.05) (Fig. 6G; Supplementary Fig. 16). Positive and negative controls had zones of 23–33 mm and 0.01–0.03 mm, respectively (Fig. 6H, I, R–U).
Antimicrobial activity of selected crude extracts assessed by MIC
In this study, the antimicrobial activity of selected crude extracts was evaluated using the minimum inhibitory concentration (MIC) assay to determine their effectiveness against specific microbial strains. The results provide insight into the potential of these extracts as sources of antimicrobial agents.
The MIC and optical density (OD) values of the selected crude extracts are summarized in Supplementary Tables 5 and 6. MIC assays revealed differential antimicrobial potency among tested samples against Pseudomonas aeruginosa, Staphylococcus aureus, and Aspergillus fumigatus. The observed MIC values spanned a broad range, from 0.39 to 50 mg/mL, across the tested microbial strains. Sample 9B exhibited the most pronounced antibacterial activity, demonstrating potent inhibition of S. aureus at an exceptionally low MIC of 0.39 mg/mL, while sample 16A also showed activity against S. aureus with an MIC of 3.125 mg/mL (Fig. 7A–D). Against P. aeruginosa, sample 5B showed improved efficacy (25 mg/mL) relative to sample 1B (50 mg/mL), indicating enhanced anti-pseudomonal potential (Fig. 7E–H). Notably, antifungal screening revealed sample 5C as the most active against A. fumigatus (0.781 mg/mL), whereas sample 7A exhibited moderate inhibition (6.25 mg/mL) (Fig. 7I–L). These findings underscore the selective and potent antimicrobial profiles of specific samples, particularly against Gram-positive bacteria and filamentous fungi. These results establish a foundational basis for selecting appropriate concentrations to further evaluate the inhibitory effects of the samples against bacterial and fungal biofilms.
The antimicrobial activity of selected extracts was determined using a broth dilution assay (Supplementary Table 6). The figure is organized by pathogen, with each tested extract represented by two corresponding panels: the prepared serial dilution series and the final MIC assay result after a standardized incubation period. For all extracts, the dilution series ranges from C1 (50 mg/mL) to C10 (0.098 mg/mL). The MIC is defined as the lowest concentration that completely inhibits visible microbial growth. A–D Antibacterial activity against Staphylococcus aureus after 24 hours of incubation in the nutrient broth. A, B The serial dilution and corresponding assay for Extract 9B, which exhibited an MIC of 0.39 mg/mL (tube C8). (Note: The dedicated growth control tube for panel B was inadvertently omitted during image capture; however, vigorous turbidity in tubes C9-C10 serves as a clear internal positive reference for microbial growth, confirming that the absence of the control tube in the image does not affect the interpretation of the MIC value). C, D The serial dilution and corresponding assay for Extract 16A, which exhibited an MIC of 3.125 mg/mL (tube C5). E–H Antibacterial activity against Pseudomonas aeruginosa after 24 hours of incubation in the nutrient broth. E, F The serial dilution and corresponding assay for Extract 1B, showing an MIC of 50 mg/mL (tube C1). G, H The serial dilution and corresponding assay for Extract 5B, showing an MIC of 25 mg/mL (tube C2). I–L Antifungal activity against Aspergillus fumigatus after 48 hours of incubation in Sabouraud Dextrose (SD) broth. I, J The serial dilution and corresponding assay for Extract 5C, revealing an MIC of 0.781 mg/mL (tube C7). K, L The serial dilution and corresponding assay for Extract 7A, revealing an MIC of 6.25 mg/mL (tube C4). Controls: for all assays, controls were run in triplicate. The sterility control (media broth only) confirmed the absence of contamination. The growth control (broth + inoculum) confirmed organism viability. The positive control consisted of broth with inoculum and a standard inhibitor (0.1 mg/mL ciprofloxacin for bacteria; 0.35 mg/mL itraconazole for fungi).
Comparative GC-MS profiling reveals phytochemical diversity
Gas chromatography-mass spectrometry (GC-MS) profiling of the crude extracts revealed substantial variations in phytochemical diversity, clearly distinguishing the wild plant from the in vitro cultures. The wild plant extract (sample 16) was the most chemically complex, yielding 96 detectable components across a broad elution time of 9.00–52.00 minutes. In contrast, the callus extracts exhibited significantly lower complexity in a clear descending order: sample 1 (36 components; 9.20–51.00 min), sample 7 (28 components; 9.20–50.50 min), sample 9 (14 components; 18.80–49.00 min), and sample 5 (13 components; 18.80–47.90 min). This gradient underscores a marked difference between the rich metabolic profile of the intact plant and the simplified profiles of the lab-grown cultures (Supplementary Fig. 13, Supplementary Tables 7–11).
For a robust semi-quantitative comparison, the dataset was refined to 22 consistently detected compounds. Sample 1, which contained the most comprehensive profile among the callus extracts (18 of 22 compounds), was selected as the experimental control for calculating the relative abundance of these analytes. This comparative analysis highlighted three significant, condition-specific trends: (1) an enrichment of stable, high-molecular-weight compounds; (2) a notable depletion of labile fatty acid esters; and (3) the unique appearance of specific metabolites in treated samples compared to the control (Table 3).
A subset of compounds demonstrated substantial increases in relative abundance compared to the control. Notably, the antioxidant-related compound 7,9-Di-tert-butyl-1-oxaspiro(4,5)deca-6,9-diene-2,8-dione exhibited over a fourfold increase in both Sample 7 (5.668-fold) and Sample 16 (4.429-fold). Similarly, the long-chain alkane Tetrapentacontane (C₅₄) was enriched by more than fivefold in Sample 16 (5.341-fold).
Marked elevations were also observed among phthalate esters. Phthalic acid, di(2-propylpentyl) ester increased nearly threefold in Sample 7 (2.875-fold), while 1,3-Benzenedicarboxylic acid, bis(2-ethylhexyl) ester rose fourfold in Sample 16 (4.028-fold). The lipid amide 13-Docosenamide, (Z)- also accumulated significantly, reaching more than twofold in both Sample 7 (2.1-fold) and Sample 16 (3.8-fold).
In contrast, several fatty acid methyl esters (FAMEs) were markedly depleted. The greatest reductions were seen in 9-Octadecenoic acid, methyl ester, (E)-, which dropped to 0.088-fold of control levels in Sample 5, and Hexadecanoic acid, methyl ester, reduced to 0.181-fold in Sample 9. Other FAMEs, such as 9,12-Octadecadienoic acid (Z,Z)-, methyl ester and Benzenepropanoic acid, 3,5-bis(1,1-dimethylethyl)-4-hydroxy-, ethyl ester, were consistently depleted across most samples, often with relative abundances below 0.5-fold.
Additionally, several compounds were detected exclusively in treated samples and were absent in the control, suggesting possible de novo synthesis, environmental introduction, or enhanced stability under treatment conditions. These included the terpenoid hydrocarbons Neophytadiene and Squalene, as well as the plasticizer 1,4-Benzenedicarboxylic acid, bis(2-ethylhexyl) ester, which was present only in Samples 5 and 9.
APX activity and its correlation with artemisinin content and antimicrobial potential
APX antioxidant activity (µmol min−1 g−1 FW) was assessed for all crude sample extracts. Sample 1 exhibited the highest mean APX activity (635 µmol min−1 g−1 FW), which was significantly greater than that of all other samples (p < 0.02022) (Fig. 8A). Sample 13 showed the second highest mean APX activity (183 µmol min−1 g−1 FW), followed closely by sample 5 (103 µmol min−1 g−1 FW); however, their difference was not statistically significant (p > 0.05). The lowest APX activities were recorded in samples 3 (11.9 µmol min−1 g−1 FW) and 2 (15.9 µmol min−1 g−1 FW), with no significant difference between them (p > 0.05).
A Ascorbate peroxidase (APX) activity across all sixteen treatment groups. B–E Correlation analysis between APX activity and artemisinin content (B), antibacterial activity against S. aureus (C), antibacterial activity against P. aeruginosa (D), and antifungal activity against A. fumigatus (E). Treatment details (1–16) are as follows: Treatment 1: 1 mg/L BAP + 1 mg/L 2,4-D; Treatment 2: 5 mg/L BAP + 1 mg/L NAA; Treatment 3: 1 mg/L KN + 1 mg/L NAA; Treatment 4: 1 mg/L BAP + 1 mg/L 2,4-D + 0.5 mg/L AgNO3; Treatment 5: 1 mg/L BAP + 1 mg/L 2,4-D + 1.0 mg/L AgNO3; Treatment 6: 1 mg/L BAP + 1 mg/L 2,4-D + 2.0 mg/L AgNO3; Treatment 7: 5 mg/L BAP + 1 mg/L NAA + 0.5 mg/L AgNO3; Treatment 8: 5 mg/L BAP + 1 mg/L NAA + 1.0 mg/L AgNO3; Treatment 9: 5 mg/L BAP + 1 mg/L NAA + 2.0 mg/L AgNO3; Treatment 10: 1 mg/L KN + 1 mg/L NAA + 0.5 mg/L AgNO3; Treatment 11: 1 mg/L KN + 1 mg/L NAA + 1.0 mg/L AgNO3; Treatment 12: 1 mg/L KN + 1 mg/L NAA + 2.0 mg/L AgNO3; Treatment 13: 1 mg/L BAP + 1 mg/L 2,4-D + 1.0 mg/L AgNO3; Treatment 14: 5 mg/L BAP + 1 mg/L NAA + 1.0 mg/L AgNO3; and Treatment 15: 1 mg/L KN + 1 mg/L NAA + 1.0 mg/L AgNO3; and Treatment 16: Wild A. annua leaf extract (six-week-old; 3rd–5th node). Data are presented as mean ± standard error (SE), and bars with different letters indicate statistically significant differences according to Tukey’s HSD test (p ≤ 0.05).
To explore potential relationships, correlation analyses were performed between APX activity and artemisinin concentration, as well as antimicrobial activity against three clinically relevant pathogens. Correlation coefficients (r) were calculated, and statistical significance was set at α = 0.05. Results indicated poor and mostly non-significant correlations: APX activity and artemisinin concentration (r = 0.083, p > 0.576); APX activity and S. aureus inhibition (r = –0.103, p > 0.486); APX activity and A. fumigatus inhibition (r = 0.038, p > 0.800). A weak but statistically significant correlation was observed only between APX activity and P. aeruginosa inhibition (r = 0.296, p < 0.041) (Fig. 8B–E).
Discussion
The use of medicinal plants in ethnopharmacology and traditional medicine, particularly in systems like African, Chinese, and Indian medicine, dates back millennia, with modern genetic engineering expanding their applications through biotechnological platforms such as callus and cell suspension cultures. Callus and cell suspension cultures offer scalable, contamination-free systems for year-round phytochemical production, independent of environmental constraints. Typically, a biphasic protocol—cell proliferation followed by elicitor-induced biosynthesis—is employed to enhance yields. This strategy has proven effective for producing taxanes, alkaloids, and other high-value metabolites, often via biotic or abiotic elicitors that simulate stress responses46,47,48. Coupling callus culture with metabolic engineering—via gene overexpression, RNAi, or CRISPR—further boosts biosynthetic flux and enables the generation of novel compounds49,50,51. These approaches support sustainable, large-scale production of plant-based therapeutics, minimizing wild harvesting and aligning with circular bioeconomy goals. In this context, elicitor-driven modulation of in vitro cultures emerges as a powerful tool at the interface of plant science, biotechnology, and translational research for sustainable bioproduction. These in vitro systems are essential for producing bioactive compounds, developing disease-resistant crops, and enabling rapid propagation, while also offering solutions for biodiversity conservation52,53,54,55,56,57. Bioengineering harnesses these platforms for producing tailored biologics, supporting the sustainable production of pharmaceuticals, nutraceuticals, and industrial products. Advances in biosynthetic pathway elucidation, CRISPR-based genome editing, and metabolic engineering optimize callus cultures for consistent, scalable yields of high-value phytochemicals and functional ingredients. Despite being underutilized, callus technology holds significant potential for climate-resilient, standardized production and bridging traditional knowledge with modern biotechnology16,49. This study advances a dual-purpose strategy using A. annua callus cultures as both a phytochemical reservoir and a model for stress-response research, establishing mechanistic links between plant tissue engineering, plant growth regulation, oxidative stress, and bioactive compound biosynthesis, and positioning callus-based platforms for sustainable phytopharmaceutical production and bio-functional innovation.
Plant tissue culture, founded on the principle of cellular totipotency and standardized through media such as Murashige and Skoog (MS), facilitates the regeneration of whole plants or the induction of callus from somatic cells under defined in vitro conditions. Manipulation of growth regulators (e.g., auxins, cytokinins), nutrient composition, and culture parameters (25 ± 2 °C, 16 h photoperiod, humidity control) facilitates callus formation and metabolite production49,52,53,54,55,56,57,58,59. Callus induction underpins numerous in vitro plant culture protocols essential for metabolic engineering and genetic transformation. Multiple pathways, including auxin-, cytokinin-, wound-responsive, and cell wall remodeling routes, converge to initiate callus formation60,61,62,63,64. Although the cellular origin remains under study, auxin transport via PIN-FORMED (PIN) proteins and TEOSINTE BRANCHED1/CYCLOIDEA/PROLIFERATING CELL FACTOR (TCP) transcription factors are central to cellular reprogramming and cell cycle re-entry49. Quiescent cells re-enter the cycle through reactivation of core regulators such as CYCLINs and CDKs61. Wounding activates AP2/ERF transcription factors—WIND1–4—which drive dedifferentiation and callus formation; overexpression of WIND1/2 can bypass wounding altogether60,61. Hormonal inducers like auxin and cytokinin also trigger callus development on callus-inducing media (CIM), which often follows a root developmental program62. CIM-induced calli mimic root primordia, marked by WUSCHEL-RELATED HOMEOBOX 5 expression62. In wounded leaf explants, local auxin accumulation activates WOX11, initiating root founder cell identity and division, followed by WOX5 expression in root primordium cells63. This suggests overlaps and distinctions between CIM- and wound-induced pathways. Concurrently, LATERAL ORGAN BOUNDARIES DOMAIN transcription factors and PLETHORA proteins (PLT3, PLT5, PLT7) promote root meristem identity through activation of PLT1 and PLT2, establishing organogenic competence in calli62.
In this study, callus initiation from A. annua leaf explants represented a critical prerequisite for subsequent experimental phases. To identify the most effective conditions, thirteen plant growth regulator (PGR) combinations were evaluated for their callus induction potential (Table 4). Four treatments induced callus formation, but only the top three—based on callus induction frequency and intensity—were selected for further experimentation (Table 1 and Fig. 3). Notably, treatments with individual PGRs (BAP, KN, NAA, or 2,4-D) or with cytokinin–cytokinin or auxin–auxin pairings were ineffective (Table 3). Only specific cytokinin–auxin combinations produced consistent callus formation or shoot morphogenesis (Table 4, Supplementary Fig. 3). These findings reinforce the classical model proposed by Skoog and Miller (1957), highlighting the pivotal role of cytokinin-to-auxin ratios in determining the developmental fate of plant explants65.
Among the three tested plant growth regulator (PGR) treatments, Treatment G (5 mg/L BAP + 1 mg/L NAA) produced the most robust callus response, characterized by compact, non-friable calli with dark green to pale yellow pigmentation—traits suggestive of active cell division and high viability (Fig. 3). Treatment F (1 mg/L BAP + 1 mg/L 2,4-D) yielded a moderately effective response, forming compact calli with variable pigmentation (pale yellow to dark brown and occasional green) (Fig. 3). In contrast, Treatment L (1 mg/L KN + 1 mg/L NAA) resulted in predominantly dark brown, dense calli, demonstrating lower induction efficiency than treatments G and F (Fig. 3). These observations align with findings by Mohammad et al.66, who reported enhanced callogenesis in A. annua using BAP (0.1–1.0 mg/L) with NAA (0.5–2.0 mg/L), producing friable, vigorously growing calli under light. While BAP + 2,4-D combinations were less effective, TDZ (Thidiazuron) + 2,4-D (especially 0.5 mg/L TDZ + 1.0 mg/L 2,4-D) yielded superior callus morphotypes but resulted in lower biomass accumulation compared to BAP + NAA. Biomass peaked under light with BAP (1.0 mg/L) + NAA (2.0 mg/L), achieving up to 0.13 g dw/explant in transgenic and 0.10 g dw/explant in non-transgenic cultures, nearly double the values observed in darkness. Despite its higher induction potential, TDZ combinations showed the lowest biomass yield (0.07 g dw/explant), while BAP + 2,4-D treatments produced intermediate results66. The higher efficacy of NAA in promoting callus vigor and biomass may stem from its positive influence on photosynthetic efficiency, organ development, and acclimatization, as demonstrated in Aechmea blanchetiana and other species67. Furthermore, NAA’s rooting efficacy is enhanced under blue light, which activates developmental genes like CmLBD1, underscoring the importance of light–PGR interactions in optimizing morphogenic responses68,69.
The effects of synthetic auxins on plant tissue development diverge significantly depending on their concentration and the plant’s sensitivity. While compounds like NAA and 2,4-D mimic natural auxins (e.g., indole-3-acetic acid (IAA)), their influence becomes increasingly disruptive at higher concentrations. In particular, 2,4-D, known for its stability and prolonged activity, frequently overrides endogenous auxin regulation, provoking aberrant hormonal signaling. This deregulation disturbs auxin homeostasis, disrupts hormonal crosstalk, and can suppress chlorophyll biosynthesis—especially in dicot species—by interfering with photosynthetic and developmental pathways70,71. In tissue culture, auxin selection is critical. NAA exhibits less inhibitory impact on chlorophyll synthesis than 2,4-D, as it supports partial chlorophyll retention and organized growth, including shoot regeneration. Conversely, 2,4-D impairs chloroplast integrity and photosynthetic activity in a concentration-dependent manner. The herbicidal action of 2,4-D is classically described in three progressive phases: an initial ethylene burst (via ACC synthase activation), leading to abscisic acid (ABA) accumulation and tissue swelling; a second phase of abnormal development marked by reduced elongation, reactive oxygen species (ROS) accumulation, and stomatal closure; and a terminal phase characterized by chlorosis, chloroplast degradation, and cell death72. Experimental evidence supports these mechanistic distinctions. For instance, Paniego and Giulietti (1994) observed that NAA (5.4 µM), either alone or with 6-benzylaminopurine (BAP or 6-BA) (5.4/0.22 and 5.4/0.66 µM), produced compact, green calli from A. annua explants under both light and dark conditions, with faster dedifferentiation and more vigorous tissue under photoperiodic regimes. In contrast, 2,4-D (4.5 µM) induced friable callus ranging from white to brown, with slower growth and earlier browning in the dark. Notably, calli induced by NAA exhibited a higher specific growth rate (μ = 0.060 day−1) than those treated with 2,4-D (μ = 0.022 day−1), indicating superior metabolic efficiency and stability73. These trends are further echoed in Gymnema sylvestre R.Br cultures, where 2,4-D yielded albino, spongy, high-moisture callus, while NAA generated yellowish-green, friable tissue, and BA (or 6-BA) produced robust, dark green callus with maximal biomass74. An optimized combination of 2,4-D, NAA, and BA promoted high-yield callus without browning; however, excessive NAA ( > 5.0 mg/L) induced tissue necrosis after three weeks74. Such outcomes underscore the species- and dose-dependent nature of auxin action and highlight the fine line between growth promotion and deregulation.
A wealth of evidence supports the efficacy of specific plant growth regulator (PGR) combinations—most notably BAP and NAA—in inducing callogenesis from A. annua leaf explants cultured on Murashige and Skoog (MS) medium. Chenshu et al. demonstrated successful callus induction with 1 mg/L NAA and 0.5 mg/L 6-BA under controlled conditions, while Bartarya et al. achieved similar results using significantly lower concentrations (0.03 mg/L NAA, 0.2 mg/L BAP)75,76. Ganesan and Paulsamy (2011) validated the callogenic potential of 0.9 mg/L NAA, and Dangash et al. reported a 100% induction rate using 0.5–1.5 mg/L BAP with 0.05 mg/L NAA77,78. Further refinement was provided by Tahir et al.79, who identified 0.5 µM of both BAP and NAA as optimal for initiating high-frequency callogenesis (94%) in the Chiyong variety79. Zebarjadi et al. extended these findings by enhancing both callus formation (100%) and artemisinin yield with 1.5 mg/L BAP and 3 mg/L 2,4-D80. Keong et al. reported maximal callus biomass using 0.5 mg/L each of BA and NAA with 0.5 g/L casein hydrolysate, while the inclusion of picloram improved both friability and yield81.
The present findings reinforce earlier observations by Mohammad et al.66, who reported approximately 1.5-fold increase in transgenic callus biomass when cultured on MS medium containing BAP (1.0 mg/L) and NAA (2.0 mg/L), as compared to BAP (1.0 mg/L) combined with 2,4-D (0.5 mg/L). In line with these results, this study demonstrated increased biomass accumulation under the same hormonal regime, highlighting the effectiveness of BAP–NAA synergy. While Lei et al. successfully achieved shoot regeneration in A. annua using a medium supplemented with BAP (1.0 mg/L) and NAA (0.05 mg/L), such responses are highly species-specific44. Indeed, Campanoni and Nick (2005) provided mechanistic insight into the divergent roles of auxins: NAA fosters cell elongation and organized growth at low concentrations, supporting structured proliferation, whereas 2,4-D triggers G-protein-mediated cell division but promotes dedifferentiation and the formation of friable, unstructured callus82. These auxins thus modulate distinct developmental programs, with NAA favoring morphogenic competence and 2,4-D facilitating unregulated proliferation. The observed biomass enhancement likely arises from the complementary action of BAP and NAA, which together stimulate metabolic efficiency, nutrient uptake, and pigment retention. Supporting this, Rahman et al. identified BAP (3.0 mg/L) + NAA (3.0 mg/L) as the most effective combination for inducing high dry weight callus (2.776 g) in Catharanthus roseus, outperforming kinetin- and 2,4-D-based treatments83. Likewise, in Aquilaria malaccensis, Jayaraman et al. optimized a cell suspension culture using BAP (2.2 μM) + NAA (1.1 μM), yielding friable callus with high biomass, further substantiating the broad applicability of this hormonal synergy in promoting effective callus proliferation across species84.
Despite their widespread use, BAP + 2,4-D combinations frequently yield suboptimal biomass, largely due to 2,4-D-induced stress responses that redirect metabolism toward secondary rather than primary growth. However, under optimized conditions, this pairing can support both robust callogenesis and enhanced metabolite biosynthesis. For instance, in Vaccinium corymbosum, cell suspension cultures treated with BAP (0.45–2.25 µM) and 2,4-D (0.34–2.25 µM) achieved high biomass alongside elevated phenolic accumulation85. Similarly, Salvia tebesana cultures showed 100% callus induction across several combinations of BAP and 2,4-D (0.5, 1.0, and 1.5 mg/L). Furthermore, the peak biomass and the highest polyphenol content—which strongly correlated with antioxidant activity (DPPH r² = 0.896; FRAP r² = 0.946)—were achieved with 1.5 mg/L 2,4-D + 0.5 mg/L NAA and one of the aforementioned BAP and 2,4-D combinations, respectively86. Further supporting this paradigm, Bano et al. demonstrated that 1 mg/L each of BAP and 2,4-D, augmented with 1.5 mg/L melatonin, significantly enhanced callus and metabolite production in Salvia moorcroftiana87. In Crataegus azarolus, a higher auxin-to-cytokinin ratio (1 mg/L BAP + 2 mg/L 2,4-D) favored secondary metabolite accumulation, albeit with reduced biomass88. Coffea arabica responded with efficient callogenesis (49%) using a 1:2 BAP-to-2,4-D ratio, facilitating elite clone propagation89, while Moringa oleifera displayed complete induction and regeneration under 2,4-D-supplemented protocols, outperforming NAA90. Moreover, Trachyspermum ammi cultures showed maximum callogenic traits with leaf explants treated with 0.25 mg/L BAP + 2 mg/L 2,4-D91. In Brassica napus, Borjian et al. reported a twofold increase in callus yield with hypocotyl explants cultured on BAP, NAA, and 2,4-D, highlighting synergistic effects92. Lastly, Nigella sativa exhibited peak biomass and antioxidant activity when cultured with TDZ and NAA (4.0 mg/L; each), underscoring the critical role of PGR composition and culture duration93. Collectively, these findings affirm that auxin–cytokinin combinations—though species-specific in response—remain pivotal in optimizing both biomass and phytochemical outputs in plant tissue culture systems.
The choice of plant growth regulators (PGRs) proved critical in dictating the morphogenic fate of A. annua explants. The results revealed that BAP was more effective than kinetin (KN) in promoting callus proliferation, particularly in combination with either NAA or 2,4-D (Table 4, Fig. 3, Supplementary Figs. 4 and 5). Furthermore, the auxin type determined the developmental outcome: NAA combinations predominantly favored callus formation, whereas certain 2,4-D combinations induced direct shoot organogenesis, highlighting a precise hormonal threshold for developmental reprogramming (Table 1). These findings, while corroborating some reports on cytokinin efficacy74, stand in contrast to others that document different optimal PGR combinations for A. annua regeneration73,94,95,96,97. This variability underscores a well-established principle that the efficacy of PGR regimes is highly context-dependent, varying with species, explant source, and genotype, thereby necessitating system-specific optimization73. Such optimization is critical not only for maximizing proliferation but also for preventing deleterious physiological disorders. Notably, high concentrations of cytokinins like BAP are known to induce hyperhydricity—an aberration characterized by excessive tissue hydration and structural fragility that severely compromises culture viability98,99,100. Therefore, the systematic evaluation of multiple PGR combinations, as performed in this study, is a prerequisite for establishing a robust and reproducible protocol that balances high morphogenic potential with physiological stability, ensuring consistent outcomes while mitigating such risks.
Silver (Ag), increasingly prevalent due to anthropogenic inputs—mining, industrial discharge, and nanoparticle use—poses environmental risks despite its natural trace occurrence101. In plants, Ag acts primarily via its ionic form, with silver nitrate (AgNO₃) commonly studied for its solubility and biological activity. Ag⁺ disrupts redox balance by inducing excessive reactive oxygen species (ROS), triggering lipid peroxidation and cellular damage, as indicated by elevated malondialdehyde (MDA) levels24,101,102. Paradoxically, AgNO₃ also serves biotechnological functions, notably in morphogenesis, ethylene inhibition, and flowering induction44,103,104,105. Emerging evidence reveals its role in modulating secondary metabolism, particularly under stress. In species such as Melia azedarach, Cucumis sativus, Brassica napus, and Rosa canina, AgNO₃ elicits a biphasic response: oxidative stress alongside activation of pathways for phenolics, flavonoids, and terpenoids—compounds with recognized antioxidant and antimicrobial activities102,106,107,108. This dual role—phytotoxicant and metabolic elicitor—positions AgNO₃ as a valuable tool in stress-induced biosynthesis of high-value metabolites. Elucidating its physiological and metabolic effects is essential to optimize its application in plant tissue culture and metabolic engineering in A. annua.
After 6 weeks in culture, elicited and non-elicited callus cultures exhibited distinct morphological and physiological responses. Cultures under treatment F (1 mg/L BAP + 1 mg/L 2,4-D), irrespective of elicitor supplementation, exhibited a predominantly greenish hue with pale brown or yellow tones and a non-friable texture (Fig. 4E–S). In contrast, those exposed to treatments G (5 mg/L BAP + 1 mg/L NAA) or L (1 mg/L KN + 1 mg/L NAA) developed a brown to dark brown coloration with yellow and non-friable characteristics (Fig. 4E–S). These observations suggest that treatment F conferred a superior adaptive response to oxidative stress, potentially mitigating phenolic oxidation and tissue browning. Browning, commonly linked to cell wall lignification—a hallmark of oxidative stress—was more pronounced in treatments G and L, indicating compromised redox homeostasis. Thus, treatment F appears more effective in preserving morphological integrity and reducing stress-induced discoloration.
2,4-dichlorophenoxyacetic acid (2,4-D), a synthetic auxin analog, is extensively employed in plant tissue culture for its robust ability to induce callus formation by mimicking indole-3-acetic acid (IAA) and promoting cellular dedifferentiation. Its efficacy was underscored in Gazania rigens, where Huda E. Mahood et al. demonstrated optimal callus induction from stem (90% at 1.5 mg/L) and leaf explants (80% at 1 mg/L) within 4 weeks, affirming its auxinic potency109. However, its phytotoxic potential at elevated concentrations warrants caution. In Coffea arabica and C. canephora, João Paulo de Morais Oliveira et al. observed that while 2,4-D enhanced somatic embryogenesis, it concurrently triggered abnormal somatic embryo formation, increased global DNA methylation, and induced DNA damage—hallmarks of genotoxic and epigenetic stress, which intensified with dose escalation110. Similarly, Baklouti et al. reported that high 2,4-D levels in Phoenix dactylifera negatively impacted chlorophyll content and growth while elevating oxidative stress markers such as proline, hydrogen peroxide, and malondialdehyde111. Despite these stress responses, the explants retained regenerative potential, suggesting a complex interplay between stress induction and morphogenetic competence. Molecular analyses, including ISSR profiling and DNA methylation assays, confirmed 2,4-D’s capacity to elicit both genetic and epigenetic variations, positioning it as a key driver of somaclonal variation111. Complementary findings by Morini et al. in quince (BA 29) further support the dose- and context-dependent nature of 2,4-D’s effects, wherein higher concentrations and prolonged exposure enhanced callogenesis and modulated morphogenic trajectories in interaction with light quality and induction duration112. Collectively, these studies highlight the dualistic nature of 2,4-D as both a morphogenic enhancer and a potential epigenetic and genotoxic stressor, underscoring the necessity of concentration optimization to balance regeneration efficacy with genomic stability.
The concentration-dependent effects of auxins such as 2,4-D, IAA, IBA, and NAA are well-documented18. Notably, NAA (1-naphthaleneacetic acid) is generally less phytotoxic than 2,4-D (2,4-dichlorophenoxyacetic acid). While IAA, IBA, and NAA typically promote growth, 2,4-D often exhibits herbicidal activity, occasionally producing effects opposite to other auxins at comparable concentrations113. In this study, the combination of BAP and 2,4-D paradoxically conferred greater oxidative stress tolerance than BAP + NAA (Fig. 8). Cytokinins such as BAP are critical regulators of chlorophyll biosynthesis, photosynthesis, biomass accumulation, antioxidant capacity, and stress resistance, ultimately enhancing plant growth and resilience114. Exogenous BAP enhances abiotic stress tolerance by boosting chlorophyll content, photosynthetic efficiency, carbon metabolism, and antioxidant defense mechanisms (by activating ROS-scavenging enzymes)114. Consistent with these roles, the findings of this study suggest that BAP + 2,4-D synergistically reinforced antioxidant defenses and reduced the morphological symptoms of oxidative stress more effectively than BAP + NAA. This likely accounts for the superior stress adaptation observed in treatment 1 (1 mg/L BAP + 1 mg/L 2,4-D), followed by treatments 13 and 5 (each comprising 1 mg/L BAP + 1 mg/L 2,4-D + 1 mg/L AgNO₃). However, supplementation with AgNO₃ appeared to diminish the protective effects, indicating that silver ion-induced stress partially overrode the benefits conferred by the PGR combination (BAP + 2,4-D). Furthermore, subculturing calli from treatment 1 into MS medium supplemented with AgNO₃ exacerbated the reduction in oxidative stress tolerance, suggesting that repeated subculture and habituation phenomena in vitro may influence adaptive responses, potentially through epigenetic or phenotypic modifications115,116.
Treatment 14 (5 mg/L BAP + 1 mg/L NAA + 1 mg/L AgNO₃) yielded the highest fresh weight, dry weight, and crude extract outputs, indicating a preferential synergistic effect between AgNO₃ and the PGR combination of BAP and NAA (Fig. 4). This result corroborates the findings of Lei et al., who demonstrated enhanced callus and shoot formation from A. annua leaf explants on MS media supplemented with similar PGRs (BAP + NAA) and silver nitrate. In their study, the inclusion of 2 mg/L AgNO₃ notably increased shoot induction frequency and shoot numbers per explant, while also promoting early shoot elongation within 20 days44. Consistently, silver nitrate across various concentrations favored biomass accumulation and shoot morphogenesis over callus proliferation. There is a critical distinction between treatment 14 and treatment 8, despite identical media compositions: in treatment 14, explants were cultured directly in media containing AgNO₃, whereas in treatment 8, callus derived under PGR-only conditions was subsequently transferred to AgNO₃-supplemented media (Table 2). The superior performance observed in Treatment 14 highlights the critical role of immediate exposure to elicitor-supplemented PGR media at the culture initiation phase, which significantly enhanced direct callus induction and biomass accumulation. In contrast, repeated subculturing was associated with diminished callus vigor, indicating a negative correlation between biomass output and successive subculturing cycles. These findings support the notion that early-stage elicitor-PGR synergy is key to maximizing biomass yield. Nevertheless, the use of a single elicitor concentration (1 mg/L AgNO₃) in this setup limits the ability to conclusively define it as optimal for biomass enhancement in A. annua callus cultures. While Treatment 14 demonstrated superior efficacy under the tested conditions, determining the true concentration-dependent response of AgNO₃ would require a systematic elicitor optimization protocol, including a broader concentration gradient. Such optimization was beyond the scope of the current study but remains essential for refining the elicitor-PGR interaction matrix for scalable biotechnological applications. Furthermore, although treatments 1 (1 mg/L BAP + 1 mg/L 2,4-D) and 11 (1 mg/L KN + 1 mg/L NAA + 1 mg/L AgNO₃) induced callus formation, they exhibited lower callus intensity and biomass compared to treatment 14. Interestingly, crude extract yield from treatment 1 was comparable to treatment 14, suggesting that the BAP + 2,4-D combination, despite reduced biomass, more effectively stimulated secondary metabolite production—likely due to a favorable balance between dedifferentiation and metabolic activation. This finding positions the BAP + 2,4-D system as a superior elicitor for maximizing phytochemical yield in A. annua callus cultures under in vitro conditions, independent of silver nitrate or elicitor supplementation.
Terpenoids (isoprenoids) form the largest class of plant secondary metabolites, comprising over 80,000 structurally diverse compounds with key roles in development, defense, and stress adaptation117. Their biosynthesis stems from two compartmentalized pathways: the plastidial MEP pathway, producing monoterpenes, diterpenes, and carotenoids; and the cytosolic MVA pathway, yielding sesquiterpenes, sterols, and brassinosteroids. Both converge at isopentenyl pyrophosphate (IPP) and dimethylallyl pyrophosphate (DMAPP), the core five-carbon precursors117. Terpenoid diversity is driven by the catalytic plasticity of terpene synthases (TPS), which mediate the stereospecific cyclization of prenyl diphosphates and respond dynamically to environmental cues117. A prominent pharmacological example is artemisinin, a sesquiterpene lactone from A. annua, synthesized from MVA-derived farnesyl pyrophosphate (FPP). FPP is cyclized by amorpha-4,11-diene synthase (ADS), followed by oxidation via CYP71AV1, its P450 reductase (CPR), and dehydrogenases to form artemisinic acid. This intermediate branches toward arteannuin B or, via reduction to dihydroartemisinic acid (DHAA), proceeds through non-enzymatic photo-oxidation to yield artemisinin18,19,118. This bifurcation—modulated by enzyme specificity, redox state, and inter-pathway flux—governs artemisinin output. Deciphering its regulatory architecture is key to metabolic engineering efforts to boost yields. More broadly, A. annua offers a tractable model for designing stress-responsive terpenoid biosynthesis via synthetic biology.
Malaria remains a leading parasitic disease, with sub-Saharan Africa bearing over 95% of the 608,000 global deaths reported in 2022, disproportionately affecting children under five119,120. Caused by Plasmodium spp.—notably Plasmodium falciparum and Plasmodium vivax—and transmitted via female Anopheles mosquitoes, its pathogenicity stems from a complex intra-host cycle involving hepatic invasion, erythrocytic replication, and immune evasion. Clinical outcomes range from fever and anemia to cerebral malaria and placental complications, the latter linked to fetal growth restriction and low birth weight121,122,123. Despite a 60% decline in African malaria mortality since 2000, eradication faces key barriers. Drug resistance—driven by PfKelch13 mutations—and widespread pyrethroid resistance undermine treatment and vector control. Fragile health systems continue to impede progress in malaria control, particularly in resource-limited settings where poor diagnostic infrastructure, limited treatment availability, and inadequate funding exacerbate disease burden. The challenge is even more acute in addressing placental malaria, where therapeutic gaps persist and the pipeline for new drugs and vaccines remains stagnant124,125,126,127,128,129,130. In these contexts, access to artemisinin-based combination therapies (ACTs) is not always guaranteed, driving communities to rely increasingly on traditional plant-based remedies and herbal infusions. This longstanding reliance on medicinal plants underscores the need to explore sustainable, scalable, and scientifically grounded approaches to harness their therapeutic potential. Plant biotechnology presents a promising avenue to meet this need. In vitro tissue culture techniques, especially callus culture systems, offer controlled environments for producing bioactive secondary metabolites with pharmaceutical relevance, such as artemisinin. Beyond addressing issues of habitat loss and species endangerment, these systems enable enhanced metabolite production through precursor feeding and elicitor treatments—overcoming the often-low yields observed in natural conditions. Despite their potential, callus-based technologies remain underexploited, particularly in the development of affordable, multifunctional, and standardized formulations for human health applications. This study leverages leaf explant-derived callus cultures of A. annua as a model platform to explore the feasibility of developing a multifunctional natural supplement with standardized therapeutic potential against malaria. By decoupling environmental and biological variables inherent to field studies, the in vitro model provides a robust tool for dissecting plant stress responses, metabolite dynamics, and bioactive compound optimization24. This approach offers a sustainable alternative to conventional drug development and lays the groundwork for future innovations in botanical therapeutics, especially in addressing unmet needs in global malaria treatment.
The accumulation of secondary metabolites, particularly artemisinin, in A. annua exhibits marked variation across aerial tissues and developmental stages131. Rai et al. demonstrated a dynamic profile of artemisinin and flavonoid content, with the highest artemisinin concentration observed in leaves during the full-bloom stage (65 ± 2.9 mg 100 g−1 DW), in contrast to significantly lower levels at the seedling (3.0 ± 0.2 mg 100 g−1 DW), pre-flowering (16 ± 3.0 mg 100 g−1 DW), and post-flowering stages (14 ± 0.2 mg 100 g−1 DW). These findings underscore the critical role of ontogeny in metabolite biosynthesis. Furthermore, while treatment and developmental stage interactions significantly enhanced metabolite accumulation (p < 0.05), no synergistic effects were observed between growth stage and plant part. This indicates that secondary metabolite production is modulated by a complex interplay of growth phase and culture conditions, rather than by specific organ-stage synergies131.
In this study, high-performance liquid chromatography (HPLC) analysis revealed detectable levels of artemisinin in all forty-eight samples, comprising fifteen callus triplicates and one leaf triplicate, derived from six-week-old A. annua callus cultures and wild plant tissues harvested from the 3rd to 5th leaf positions below the shoot apex (Fig. 5, Supplementary Figs. 11 and 12). These findings indicate that artemisinin synthesis is not restricted to glandular secretory trichomes (GSTs), corroborating earlier observations by Judd et al. and suggesting broader biosynthetic competency within plant tissues132. These findings also support previous reports that the developmental stage of cultures and their exposure to plant growth regulators (PGRs), irrespective of elicitor presence, significantly influence secondary metabolite biosynthesis131. Notably, artemisinin levels in the triplicate of sample 7 were nearly undetectable, suggesting a potential somaclonal variation that resulted in low-yielding or non-producing chemotypes133,134,135 (Fig. 5 and Supplementary Fig. 12). These calli belonged to Group 2 (Table 2), which had undergone at least one subculture cycle. This is consistent with the findings of Paniego and Giulietti (1994), who observed a progressive decline in artemisinin content in undifferentiated callus over successive subcultures, likely due to genomic instability such as endoreduplication or nuclear fragmentation. Such instability may select for rapidly proliferating cell lines with diminished capacity for secondary metabolism73. The observed loss of artemisinin biosynthetic activity in sample 7 is unlikely to be attributed to treatment effects alone, as Treatment 7 (5 mg/L BAP + 1 mg/L NAA + 0.5 mg/L AgNO₃) was derived from the efficacious Treatment 1 (5 mg/L BAP + 1 mg/L NAA) with only the addition of AgNO₃ and a single subculture cycle. Given that artemisinin remained detectable in other AgNO₃-elicited samples, the elicitor is not a plausible cause of suppression. Rather, the spontaneous nature of somaclonal variation—a phenomenon known to yield both productive and non-productive genotypes—emerges as the most compelling explanation, though this remains to be validated through genomic or transcriptomic analyses in future investigations136,137,138.
The results of this study revealed that artemisinin content in wild A. annua leaves (588 µg/mL) was markedly higher than in all callus cultures, regardless of elicitation with AgNO₃ (Fig. 5). Among the callus treatments, Treatment 2 yielded the highest artemisinin level (487 µg/mL), closely followed by Treatments 14, 15, and 4 (each ~480 µg/mL). Aside from Sample 7, no statistically significant differences were observed across the remaining fourteen treatments (Fig. 5). These findings indicate that AgNO₃ elicitation and treatment variation had minimal impact on artemisinin concentration in calli. Thus, biomass accumulation and crude extract yield emerge as critical factors for evaluating treatment efficacy. Notably, Treatment 14 (5 mg/L BAP + 1 mg/L NAA + 1 mg/L AgNO₃) significantly outperformed other regimens in both parameters. When considering artemisinin content in conjunction with biomass and extract yield, Treatment 14 demonstrates the greatest potential for in vitro optimization of artemisinin production from leaf-derived callus cultures.
The findings in this study equally highlight a key limitation of using A. annua seedlings or six-week-old callus cultures as reference points for artemisinin yield, given that artemisinin accumulation is tightly linked to the plant’s developmental stage. Consistent with Rai et al., artemisinin levels peak at the full-bloom stage, where content is ~20-fold higher than in seedlings, and 4- to 5-fold higher than pre- and post-flowering stages, respectively131. Although this study compared artemisinin content in callus cultures and seedlings, a direct comparison with full-bloom plants was not done. However, a theoretical extrapolation suggests that if the artemisinin concentration in callus from treatment 14 remains significantly lower, scaling biomass production nearly 20-fold could potentially offset the difference. If validated, this raises a critical question: Can an in vitro culture system be developed to generate such high callus biomass, yielding artemisinin at commercially viable levels? Achieving this would signify a paradigm shift—substituting traditional field-based cultivation with a controlled, sustainable, and potentially more cost-effective system. This approach could reduce reliance on arable land, mitigate environmental degradation, and lower production costs for artemisinin-derived therapeutics such as artemisinin-based combination therapies (ACTs), while contributing to climate goals through reduced carbon emissions from agricultural activities57. Additionally, this study only explored the effect of a single concentration of AgNO₃ (1 mg/L) in MS media supplemented with 5 mg/L BAP and 1 mg/L NAA on callus induction (Table 2 – Group 3). A broader elicitor concentration spectrum remains unexplored. Future studies should investigate whether a wider range of AgNO₃ concentrations can further enhance callus biomass, crude extract yield, and artemisinin accumulation. Although this hypothesis lies outside the current study’s scope, it presents a promising avenue for optimizing in vitro artemisinin production systems.
Several studies have successfully demonstrated the enhancement of artemisinin biosynthesis in A. annua through strategic applications of plant growth regulators (PGRs) and elicitors. Paniego and Giulietti73 observed that artemisinin was exclusively detected in undifferentiated callus tissues, with concentrations ranging from 0.78 to 1.13 mg g−1 DW in early-stage cultures. Mohammad et al.66 further refined these insights using leaf-derived callus on MS media supplemented with BAP, NAA, 2,4-D, and TDZ. Their findings highlighted the synergistic effect of light and specific PGR combinations, where transgenic hmgr-overexpressing calli cultured under light on 1.0 mg/L BAP + 2.0 mg/L NAA yielded the highest biomass (0.13 g DW/explant), compared to lower yields under dark conditions. Notably, artemisinin content peaked at 0.006% DW in both transgenic and non-transgenic calli under light, emphasizing the dual importance of light and hormone regulation. Similarly, Keng et al.139 induced friable green callus from leaf explants using BA, NAA, 2,4-D, and IAA, with green callus yielding higher artemisinin levels. Cell suspensions elicited with KNO₃ achieved artemisinin contents of 50 µg/g DW, while elite in vitro clones exhibited levels up to 330 µg/g DW in aerial tissues. Their results underscore the superiority of nitrate ions, particularly KNO₃, over NH₄NO₃ in stimulating artemisinin biosynthesis. Zebarjadi et al.80 reported a 100% callus induction efficiency using MS medium with 1.5 mg/L BAP + 3 mg/L 2,4-D, and demonstrated enhanced artemisinin production via elicitation with GA₃ and ABA, the latter inducing a more pronounced (2.02-fold) increase. Collectively, these findings underscore the critical roles of PGR combinations, light exposure, and specific elicitors in optimizing in vitro artemisinin production pathways.
A key finding of this study was the complex and often non-linear effect of the treatments on artemisinin biosynthesis, which can be interpreted through the lens of a direct hormonal conflict centered on ethylene signaling. The experimental design created an antagonistic system: it employed silver nitrate (AgNO₃), an established inhibitor of ethylene perception, alongside auxins (NAA and 2,4-D), which are known promoters of ethylene production. The final metabolic outcome, therefore, likely reflects the net equilibrium of these opposing molecular pressures.
The inhibitory action of silver ions (Ag⁺) provides one-half of this regulatory dynamic. In A. annua, the ethylene signaling pathway is a known negative regulator of artemisinin biosynthesis, acting through the transcription factor AaEIN3 to suppress key pathway genes such as ADS and DBR220. By applying AgNO₃, an agent shown to mitigate ethylene-mediated processes and oxidative stress140, the intended effect was to relieve this transcriptional suppression, thereby promoting artemisinin accumulation.
Conversely, the auxins applied in the culture media exert an opposing effect. Auxin signaling is a primary driver of ethylene biosynthesis, principally through the transcriptional upregulation of genes encoding the rate-limiting enzyme, 1-aminocyclopropane-1-carboxylic acid synthase (ACS)141,142. This mechanism is conserved across plant species, with specific ACS isoforms being rapidly induced as primary auxin-responsive genes143,144. Thus, while AgNO₃ was applied to suppress ethylene perception; its effect was likely counteracted by the persistent presence of NAA and 2,4-D, which stimulated the biosynthesis of the same hormone.
This interpretation posits a molecular ‘tug-of-war’ where the final artemisinin content is dictated by the precise balance between auxin-induced ethylene synthesis and silver ion-mediated signal inhibition. The observed results—including instances where artemisinin levels did not significantly increase despite the presence of an inhibitor—are logically explained by this framework, in which the stimulatory effect of ethylene blockade may have been partially or fully counteracted by the simultaneous auxin-driven promotion of the ethylene pathway. This highlights a critical, nuanced interaction that must be considered in future elicitation strategies.
The results of this study demonstrate that while artemisinin was consistently detectable, its yield was not significantly altered by variations in treatment or culture conditions. This uniformity suggests a complex interplay between exogenous auxins and silver ions (Ag⁺) in modulating secondary metabolism. Ag⁺ likely penetrated the callus cells, triggering oxidative bursts and suppressing ethylene signaling by interfering with AaEIN3—a negative regulator of artemisinin biosynthesis. While transcriptomic validation of genes such as ADS, DBR2, CYP71AV1, and AaORA was beyond the study’s scope, Ag⁺ likely facilitated artemisinin accumulation by both promoting singlet oxygen (¹O₂) production and repressing AaEIN3, which relieved the transcriptional inhibition of biosynthetic genes. Conversely, the auxins NAA and 2,4-D—potentially with 2,4-D exerting a stronger effect—appeared to enhance ethylene biosynthesis via upregulation of ACS enzymes. This ethylene accumulation may have intensified ROS levels; however, its precise role in modulating artemisinin remains unclear. It is conceivable that oxidative stress, whether induced by Ag⁺ or auxins, increased singlet oxygen (1O₂) levels, contributing to both signaling events and dihydroartemisinic acid (DHAA) oxidation. Thus, while both Ag⁺ and auxins induce oxidative stress, their divergent effects on ethylene signaling—Ag⁺ suppressing and auxins promoting AaEIN3 activity—may explain the observed consistency in artemisinin content despite differing treatments.
The findings of this study indicate that silver ions (Ag⁺), despite effectively inducing secondary metabolite biosynthesis and activating oxidative stress defense mechanisms, do not enhance artemisinin production. This underscores the predominant role of Ag+ as a general stress elicitor rather than a targeted modulator of artemisinin biosynthesis. These observations are consistent with findings by Saghirzadeh et al., who examined the effects of exogenous silver nitrate and copper sulfate (Cu²⁺) on A. annua shoot cultures. Their study reported that Ag⁺ treatment reduced shoot biomass and chlorophyll content but elevated carotenoid levels, whereas Cu²⁺ improved biomass, chlorophyll, and carotenoid accumulation. Both metal ion treatments elevated oxidative stress indicators, including hydrogen peroxide (H₂O₂), lipoxygenase (LOX) activity, and malondialdehyde (MDA) accumulation, alongside increased activities of glutathione S-transferase (GST) and phenylalanine ammonia-lyase (PAL). While both Ag⁺ and Cu²⁺ stimulated phenolic compound accumulation, only Cu²⁺ at 5 µM significantly enhanced artemisinin content45. This suggests that although Ag⁺ activates broad-spectrum stress responses, it lacks specificity in promoting artemisinin biosynthesis, in contrast to Cu²⁺, which elicits a more favorable balance between stress mitigation and secondary metabolite production.
Antimicrobial resistance (AMR) is a deepening global health crisis, exacerbated by the sustained use—and often misuse—of antimicrobials in human medicine145,146. Originally introduced to combat infectious diseases, prolonged and subtherapeutic exposure has inadvertently accelerated the evolution of resistant pathogens, thereby compromising treatment efficacy. The ESKAPE pathogens—Enterococcus faecium, Staphylococcus aureus, Klebsiella pneumoniae, Acinetobacter baumannii, Pseudomonas aeruginosa, and Enterobacter spp.—remain principal drivers of healthcare-associated infections, owing to their capacity for rapid resistance acquisition, environmental resilience, and dissemination via high-risk clones145,146. Despite incremental advances, including novel antibiotics and β-lactamase inhibitors, therapeutic options remain insufficient against these multidrug-resistant organisms. The 2024 WHO Bacterial and Fungal Priority Pathogens Lists underscore this urgency, highlighting P. aeruginosa, S. aureus, and Aspergillus fumigatus as critical threats due to rising resistance profiles and limited treatment alternatives147,148. P. aeruginosa and S. aureus continue to evade both frontline and last-resort therapies, complicating infection management in clinical settings. Concurrently, A. fumigatus presents an emerging fungal challenge, particularly in immunocompromised individuals, as azole resistance becomes increasingly prevalent. These designations are intended to prioritize global research, development, and public health interventions aimed at curbing AMR and safeguarding therapeutic efficacy.
Plant-derived bioactives—including essential oils, spices, and extracts—have long been recognized for their pharmacological potential. These compounds exhibit diverse biological activities, notably antimicrobial, antioxidant, and anti-inflammatory effects. Such properties are largely attributed to their capacity to disrupt microbial cell integrity and modulate oxidative and inflammatory pathways, positioning them as promising candidates for novel antimicrobial development. In this study, n-hexane extracts from both callus and leaf tissues of A. annua demonstrated inhibitory activity against Staphylococcus aureus, Pseudomonas aeruginosa, and Aspergillus fumigatus (Fig. 6). Antimicrobial efficacy was assessed using both agar well diffusion and microdilution methods (Fig. 7, Supplementary Figs. 14–16). The two assays yielded broadly concordant results, reinforcing the robustness of the findings (Fig. 6, Supplementary Tables 5 and 6). While the agar well-diffusion method offers a rapid preliminary screen, it presents inherent limitations149. The uneven diffusion of hydrophobic compounds through agar compromises quantification, and the lack of precise extract concentration in the medium restricts interpretability to qualitative observations. Therefore, although diffusion assays are informative for initial assessments, quantitative methods such as microdilution are essential for validating antimicrobial potency (Supplementary Figs. 14–16).
The bioactivity of n-hexane extracts from A. annua callus cultures and leaves was assessed against three pathogenic microbes, revealing a differential antimicrobial profile. The most significant activity was observed against the Gram-positive bacterium S. aureus, with both wild leaf (sample 16; 17.00 ± 1.73 mm) and select callus extracts (e.g., sample 9; 14.33 ± 1.15 mm) producing substantial zones of inhibition (ZOI) (Fig. 6A). In contrast, the activity against the Gram-negative P. aeruginosa was limited. While the top-performing extracts (e.g., sample 1; 11.33 ± .53 mm and sample 5; 11.66 ± 3.06 mm) showed statistically significant inhibition compared to inactive samples, the effect size was modest (Fig. 6D). This weak activity is not entirely unexpected, as P. aeruginosa is notoriously difficult to inhibit due to its low-permeability outer membrane and efficient efflux pumps150,151. Against the fungus A. fumigatus, extracts demonstrated moderate inhibitory potential, with the best-performing samples (e.g., sample 7; 14 ± 1.73 mm) showing clear but intermediate activity (Fig. 6G). The extracts with the highest qualitative activity were selected for MIC determination to further quantify their potency (Supplementary Figs. 14–16, Supplementary Tables 5 and 6).
The observed antimicrobial activity, while variable, is consistent with the established role of the Artemisia genus as a rich source of bioactive secondary metabolites152,153,154,155,156. This study provides the first evidence of such effects from n-hexane callus extracts of A. annua against this specific panel of pathogens. While the findings of this study confirm the principle of broad-spectrum activity, the potency of the crude extracts differs from that of other preparation types described in the literature, likely attributable to the specific compounds extracted by n-hexane versus other solvents or methods.
For instance, the potent antibacterial effects noted by Govindaraju et al. were from methanolic extracts of A. annua callus and leaves157. Similarly, the robust inhibition zones (15–50 mm) against diverse bacteria, including P. aeruginosa, reported by Ćavar et al. were achieved using concentrated essential oils, which contain a different profile of volatile compounds than a solvent extract158. The significant activity against P. aeruginosa (inhibition zones up to 19 mm) found by Parameswari et al. in Artemisia nilagirica further highlights how both the plant species and the extract composition influence efficacy159. Likewise, strong antifungal activity against C. albicans was demonstrated by Roofigari et al. using different extracts of Artemisia aucheri160. Collectively, these studies corroborate that Artemisia species are a valuable source of antimicrobials. Extending this, the results of this study demonstrate that A. annua callus cultures not only produce these compounds but also yield a unique bioactive profile when extracted with n-hexane, showing a different potency level than essential oils or polar extracts.
The MIC, defined as the lowest concentration of an antimicrobial agent that prevents visible microbial growth under standardized conditions, remains the benchmark for assessing antibacterial efficacy. In this study, MIC values of n-hexane extracts from selected A. annua samples (1, 5, 7, 9, and 16) were determined using broth microdilution assays (Supplementary Tables 5 and 6). Sample 9 exhibited the strongest activity against Staphylococcus aureus, with a tenfold lower MIC (0.39 mg/mL) compared to sample 16 (3.125 mg/mL). Against Pseudomonas aeruginosa, sample 5 showed a twofold improvement in efficacy (25 mg/mL) over sample 1 (50 mg/mL). A similar enhancement was observed for Aspergillus fumigatus, where sample 5 demonstrated ~8-fold greater potency (0.781 mg/mL) than sample 7 (6.25 mg/mL). The overall antimicrobial profile—S. aureus > A. fumigatus > P. aeruginosa—correlated with the presence of thirteen to fourteen bioactive compounds identified by GC-MS analysis, highlighting the pharmacological relevance of these extracts (Supplementary Fig. 13, Supplementary Tables 5, 7–10). These observations are consistent with findings reported by Appalasamy et al., who demonstrated that artemisinin and its biosynthetic precursor, extracted from in vitro–cultured A. annua, exhibited potent antimicrobial activity at low concentrations (0.09 mg/mL) against B. subtilis, S. aureus, and Salmonella spp., comparable to streptomycin. Notably, the precursor showed superior activity against E. coli, likely due to efflux pump inhibition potentially mediated by co-extracted fatty acids. Neither compound was effective against C. albicans161. Together, the data indicate that in vitro–cultured A. annua serves as a viable and sustainable source of antimicrobial agents, offering efficacy comparable to or exceeding that of traditionally harvested material.
Evidence accumulated over the past two decades highlights the broad-spectrum antimicrobial properties of A. annua extracts and essential oils156,162,163,164,165,166,167,168,169,170. Early work by Prakash et al. reported that methanolic extracts exhibited significant activity against Pseudomonas aeruginosa (MIC: 2 mg/mL), though ineffective against E. coli and S. typhi. Massiha et al. expanded the microbial scope, showing that aqueous, methanolic, and ethanolic extracts were active against S. aureus, E. coli, Bacillus cereus, Enterococcus faecalis, and P. aeruginosa, with aqueous extracts proving particularly potent. Tajehmiri et al. demonstrated inhibition zones of 13.5–16.5 mm using methanolic and ethanolic leaf extracts against S. aureus PTCC 1431 and Salmonella enterica PTCC 1231. Donato et al. reported an MIC of 17.6 mg/mL for A. annua essential oil against E. coli O157. That same year, Kim et al. observed selective inhibition of Aggregatibacter actinomycetemcomitans by aqueous extracts, with an MIC of 14 mg/mL. Hameed et al. found methanolic extracts produced moderate inhibition zones against E. coli and S. aureus, surpassing the efficacy of certain antibiotics, though exact MICs were not provided. Raj et al. further confirmed antimicrobial activity of various solvent extracts (hexane, chloroform, acetone, methanol), with MICs ranging from 0.37 to 6 mg/mL against fungal (A. fumigatus, A. flavus, A. niger) and bacterial species, including S. aureus, Pseudomonas sp., B. subtilis, E. coli, and Klebsiella pneumoniae. Mamatova et al. extended the findings to Artemisia gmelinii, with extract MICs ranging from 1.5 to 20 mg/mL against bacterial and Candida strains. Juteau et al. reported that A. annua essential oil exhibited antimicrobial activity against Enterococcus hirae, C. albicans, and Saccharomyces cerevisiae. Most recently, Rolta et al. identified potent antibacterial effects of methanolic and petroleum ether extracts, inhibiting S. aureus and E. coli at MICs of 0.125 mg/mL and 0.65 mg/mL, respectively, and noted synergistic enhancement when combined with antibiotics. Together, these findings—spanning extract types, microbial targets, and experimental designs—consistently affirm the antimicrobial potential of A. annua, underscoring its promise as a phytotherapeutic resource for combating bacterial and fungal pathogens.
Furthermore, except for crude extract 5, which showed a direct correlation between MIC and ZOI values against P. aeruginosa (5 > 1 for both MIC and ZOI), all other extracts exhibited an inverse relationship (Supplementary Table 5 and Fig. 6). For example, against S. aureus, extract 9 had a higher MIC but a smaller ZOI compared to extract 16 (MIC: 9 > 16; ZOI: 16 > 9), and a similar pattern was observed against A. fumigatus (MIC: 5 > 7; ZOI: 7 > 5). These discrepancies likely reflect differences in drug diffusion properties, physicochemical characteristics, and strain-specific responses. While MIC is a direct measure of intrinsic potency, ZOI values depend on diffusion in agar and may not correlate linearly with MIC. Such inconsistencies underscore the importance of interpreting susceptibility data in context. The MIC remains the benchmark for quantifying antimicrobial potency, providing precise concentration thresholds (µg/mL or mg/L) required to inhibit bacterial growth in line with EUCAST and CLSI standards171,172,173,174,175,176. In contrast, the zone of inhibition (ZOI) offers a qualitative assessment influenced by diffusion dynamics and agar composition, making it more suitable for preliminary screening. Discrepancies between MIC and ZOI—for instance, large ZOIs paired with high MICs—can be clarified using hybrid assays such as the Epsilometer test (E-test), which merges diffusion and dilution principles on a single platform, or standardized broth microdilution techniques. Ultimately, MIC remains essential for guiding accurate dosing and resistance profiling. However, applying these frameworks to plant-derived antimicrobials poses unique challenges. EUCAST and CLSI guidelines were developed for well-characterized, single-molecule antibiotics and do not readily accommodate the physicochemical complexity of crude extracts. Plant extracts often consist of multiple bioactive constituents with potential synergistic interactions, necessitating higher test concentrations (commonly mg/mL rather than µg/mL) and the use of non-standard solvents. Moreover, hydrophobic compounds may exhibit limited agar diffusion, reducing ZOI clarity, or precipitate in broth, distorting MIC accuracy. Despite these limitations, both MIC and ZOI retain value in natural product screening. MIC offers a standardized, quantifiable benchmark for cross-study comparisons, while ZOI enables rapid triage of bioactive candidates. Although these metrics are not directly predictive of clinical efficacy, they are instrumental in extract prioritization, method standardization, and early-phase antimicrobial development.
This study demonstrates that plant growth regulators (PGRs) in combination with silver nitrate (AgNO₃) are effective elicitors for modulating secondary metabolism in A. annua callus cultures. A key finding, revealed by GC-MS analysis, was the inverse relationship between phytochemical diversity and antimicrobial potency. The wild plant extract (sample 16) exhibited the greatest chemical diversity (n = 96), followed by the callus extracts in descending order: 1 (n = 36), 7 (n = 28), 9 (n = 14), and 5 (n = 13) (Supplementary Tables 7-11). Unexpectedly, the most bioactive extracts (samples 5 and 9) displayed the lowest chemical diversity, suggesting that potency is driven by the concentration of specific compounds rather than overall chemical richness.
Analysis of the treatment dynamics reveals how this stress-diversity gradient was established. The combination of 5 mg/L BAP and 1 mg/L NAA proved optimal for callus induction and maintenance, whereas 1 mg/L BAP with 1 mg/L 2,4-D was comparatively less effective. The hierarchy of chemical diversity across samples directly correlated with cumulative stress exposure. Sample 16, from a wild-grown plant, displayed the highest diversity, reflecting its fully developed metabolic pathways free from induced stress. Conversely, callus-derived samples exhibited reduced diversity yet higher antimicrobial potency, particularly when subjected to high elicitor concentrations or prolonged subculturing. AgNO₃ elicitation revealed a dose-dependent effect, with higher concentrations suppressing chemical diversity, especially in the more stress-sensitive BAP + 2,4-D cultures. The data strongly imply a positive correlation between induced stress and extract potency; the most stressed cultures, such as sample 5 with its pronounced activity against both P. aeruginosa and A. fumigatus, produced the most bioactive extracts, reinforcing stress as the dominant driver of bioactivity in this context.
These phenotypic differences are rooted in the profound alterations that in vitro culture conditions induce upon the metabolic profile of A. annua callus tissue compared to the intact wild plant. The results highlight both the plasticity of secondary metabolism in cultured cells and the significant chemical gap that often exists between biotechnological production systems and their natural counterparts. The differential effects of the treatments are evident when comparing the elicited cultures (Samples 5, 7, and 9) to the baseline culture (Sample 1). The marked depletion of several fatty acid methyl esters (FAMEs) and benzenepropanoic acid derivatives in the treated samples suggests a potent induction of oxidative stress. As a well-known abiotic elicitor, AgNO₃ can trigger defensive pathways involving reactive oxygen species, which leads to lipid peroxidation and the degradation of labile antioxidant compounds177. The observed loss of these esters is therefore a consistent molecular signature of a successful, albeit catabolic, stress response within the callus cultures.
The most critical interpretation arises from comparing the in vitro profiles (Samples 1, 5, 7, 9) to the wild plant chemotype (Sample 16). While Sample 1 served as a necessary analytical control for assessing the relative effects of elicitors among the cultures, Sample 16 represents the ultimate biological benchmark. This dual-control perspective is essential: the goal is not only to compare treatments but also to understand how they modulate the callus profile relative to the natural state. This comparison reveals that the baseline callus (Sample 1) appears to overproduce certain FAMEs relative to the wild plant, suggesting that the undifferentiated state and artificial growth medium promote a metabolism fundamentally different from that of a mature leaf. Furthermore, the analysis highlights potential artifacts and environmental influences; the dramatic accumulation of phthalate esters, especially in the wild leaf extract, may reflect atmospheric deposition rather than endogenous production178,179.
Specific treatments also pushed the callus profile in divergent directions. The massive accumulation of 13-Docosenamide, (Z)- (erucamide) in both the stressed callus of Sample 7 and the wild plant of Sample 16 suggests a shift towards producing more stable, protective metabolites. In the wild plant, this lipid amide is likely a component of the protective epicuticular wax layer, and its induction in culture may signify a similar defensive strategy180. The exclusive detection of terpenoids like squalene and neophytadiene in some treated samples points to unique metabolic pathways being unmasked by in vitro stress conditions.
Collectively, the data strongly support a metabolic trade-off hypothesis, where induced stress forces the callus to reallocate resources from maintaining high chemical diversity to producing a narrower suite of potent defensive compounds. This concept is well-supported in literature; Šola et al. demonstrated that temperature stress reshapes the phytochemical landscape of Brassica oleracea, creating trade-offs between growth, nutritional profile, and stress adaptation181. Similarly, Ciriello et al. showed that salinity induces metabolic shifts in Ocimum basilicum, enhancing antioxidant compounds at the expense of yield182. The antimicrobial activity observed in the most potent extracts likely arises from the synergistic action of such stress-induced phytochemicals, particularly phenolic compounds, which are known to compromise microbial membrane integrity and inhibit metabolic enzymes169. This multi-target action underscores the therapeutic potential of extracts derived from stressed cultures.
Plants constantly face environmental stressors that elevate reactive oxygen species (ROS) such as superoxide (O₂−), hydrogen peroxide (H₂O₂), and hydroxyl radicals (•OH) (Fig.1). To mitigate oxidative damage and regulate ROS-mediated signaling, plants rely on a compartmentalized antioxidant system comprising enzymatic (superoxide dismutase (SOD), catalase (CAT), APX, glutathione reductase (GR)) and non-enzymatic (ascorbate, glutathione, flavonoids, and proline) components that preserve redox homeostasis183. Among enzymatic antioxidants, superoxide dismutase (SOD) converts O₂− to H₂O₂, which is subsequently detoxified by APX, GPX, and CAT. APX and GPX, widely distributed in organelles, use ascorbate and glutathione, respectively, while CAT—confined to peroxisomes—rapidly decomposes H₂O₂. Functional overlap among these enzymes enables adaptive flexibility, with APX and GPX often compensating for CAT deficiency17. Elicitor studies, such as AgNO₃-treated Agastache rugosa (Fisch. & C.A.Mey.) Kuntze, reveal enhanced antioxidant capacity and ROS scavenging, underscoring the role of oxidative modulation in stress resilience105.
Hydrogen peroxide (H₂O₂), compartmentalized within chloroplasts, mitochondria, the endoplasmic reticulum (ER), and plasma membrane, enables spatially controlled redox signaling essential for plant growth, development, and stress responses17. As both a signaling molecule and cytotoxic agent, H₂O₂ plays a dual role: promoting adaptive responses at low levels but causing oxidative damage—lipid peroxidation, protein carbonylation, and DNA breaks—when in excess11,15,184. However, owing to its stability and ability to traverse membranes via aquaporins, H₂O₂ also functions as a central signaling molecule in stress responses12. Nevertheless, its transient and context-dependent dynamics may constrain its reliability as a standalone stress indicator185.
Among antioxidant defenses, APX is central to the ascorbate-glutathione (AsA–GSH) cycle (also known as the Asada-Halliwell pathway), reducing H₂O₂ to water using ascorbate186,187. Its higher affinity for H₂O₂ than catalase and ubiquitous organelle-specific isoforms make it a critical regulator of redox homeostasis11,188. Unlike catalase or superoxide dismutase (SOD), APX offers both detoxification and regulatory insights due to its integration with ascorbate and NADPH-dependent pathways. Ascorbate, beyond serving as an APX substrate, directly neutralizes diverse ROS and regulates gene expression189. Its regeneration via the Smirnoff–Wheeler pathway and recycling through NADPH- and glutathione-dependent routes maintains antioxidant capacity during stress. Plants exhibit species-specific antioxidant responses, including class III peroxidases and other ROS-scavenging enzymes, which are selectively activated depending on stress type and intensity188. Under heavy metal exposure and other abiotic stresses, enhanced antioxidant activity buffers ROS toxicity and preserves cellular function190. Transgenic models overexpressing APX exhibit improved tolerance to drought, salinity, heat, and UV stress, underscoring the resilience and plasticity of plant redox regulation191.
Empirical evidence underscores its diagnostic value: APX activity consistently correlates with stress tolerance190,192, exhibits strong induction under diverse stressors191,193, and its suppression often leads to severe oxidative damage190. Moreover, APX assays offer a technically simple and reliable measure of real-time ROS scavenging, unlike the GSH/GSSG ratio, which is prone to variability185,193,194. Methods for assessing GSH:GSSG—such as liquid chromatography, mass spectrometry, spectrophotometry, capillary electrophoresis, and fluorescence microscopy—are limited by sensitivity, reproducibility, and sample preparation demands195,196. Interfering compounds and GSH autoxidation further compromise accuracy, often leading to underestimation of the GSH/GSSG ratio196,197. Although APX is a robust indicator, it is not infallible. Its efficiency depends on upstream recycling enzymes (monodehydroascorbate reductase (MDHAR), dehydroascorbate reductase (DHAR)), and post-translational inactivation under severe stress may compromise activity. Plants also deploy alternative scavenging systems—catalase, peroxiredoxins, glutathione peroxidases—that may compensate for APX loss11. Thus, comprehensive profiling combining enzymatic (APX, CAT, SOD, GR) and non-enzymatic (ascorbate, glutathione, phenolics) antioxidants with damage markers (MDA, protein carbonyls) provides a more holistic view. Nonetheless, APX remains a uniquely informative biomarker—mechanistically relevant, spatially integrated, and functionally central—offering valuable insight into plant oxidative stress resilience.
Therefore, for this initial high-throughput screening study, APX activity was used as a proxy for oxidative stress adaptation in A. annua callus cultures subjected to various plant growth regulator (PGR) combinations and silver nitrate (AgNO₃) elicitation (Fig. 8A). The highest mean APX activity was observed in cultures treated with 1 mg/L BAP + 1 mg/L 2,4-D (635 µmol min−1 g−1 FW), followed by treatment 13 and treatment 5 (183 and 103 µmol min−1 g−1 FW, respectively), which included AgNO₃ but showed reduced activity. In contrast, treatments involving 5 mg/L BAP + 1 mg/L NAA or 1 mg/L KN + 1 mg/L NAA elicited minimal mean APX activity (15.9 µmol min−1 g−1 FW and 11.9 µmol min−1 g−1 FW, respectively). Notably, treatment 14 (5 mg/L BAP + 1 mg/L NAA + AgNO₃) and wild-type leaves (treatment 16) showed comparable APX levels (~83.3 µmol min−1 g−1 FW) (Fig. 8A).
While these findings suggest that the BAP + 2,4-D combination induces a robust antioxidant response, it is important to interpret elevated APX activity not strictly as a marker of oxidative stress severity, but rather as an indicator of an active or pre-emptive ROS-scavenging system. High APX activity may signify either elevated ROS exposure or enhanced readiness for ROS mitigation, implying a well-primed antioxidant defense rather than acute oxidative damage. Conversely, low APX activity observed in treatments involving NAA (e.g., treatments 2 and 3) may reflect either insufficient stress perception or a shift toward alternative antioxidant pathways, such as catalase or superoxide dismutase (SOD). These findings align with previous studies showing that exogenous application of cytokinins, notably BAP, enhances oxidative stress tolerance. For instance, Sameena et al. demonstrated that BAP application in castor plants mitigated Cu-induced oxidative stress by reinforcing antioxidant systems, minimizing ROS accumulation, and restoring redox balance—effects that were superior to those elicited by kinetin (KN). Moreover, BAP improved stomatal conductance and photosynthetic efficiency under metal stress, underscoring its role in stress adaptation198. The current results in A. annua callus suggest that BAP, particularly when combined with 2,4-D, fosters a similar antioxidant priming effect. This raises the possibility that exploiting cytokinin-mediated stress responses, either through exogenous application or genetic engineering to elevate endogenous cytokinin levels, could be a valuable strategy in enhancing stress resilience and advancing phytoremediation efforts.
The results of this study demonstrate that the combination of BAP + 2,4-D is more effective in eliciting adaptive antioxidant responses in A. annua callus cultures than BAP + NAA. This observation is consistent with findings by Karuppanapandian et al., who reported that 2,4-D induces oxidative stress and programmed cell death in Vigna radiata seedlings, as evidenced by elevated ROS levels, lipid peroxidation, disrupted ascorbate-glutathione cycling, and activation of Ca²⁺-dependent nucleases. While 2,4-D elicited substantial oxidative stress, co-application of silver ions (AgNO₃ or AgNPs) mitigated these effects by enhancing the antioxidant defense system and delaying senescence140. These findings underscore the dual role of 2,4-D: as a potent stressor that triggers ROS accumulation and as a modulator of redox homeostasis when paired with silver-based elicitors. In contrast, Zayova et al. demonstrated that callus cultures derived from NAA/BAP combinations, particularly at 0.5 mg/L each, yielded superior regeneration and artemisinin production, with notable antioxidant potential199. However, in this study, the BAP + 2,4-D combination consistently induced higher APX activity, suggesting a more robust activation of enzymatic ROS-scavenging pathways. This contrast may reflect differences in tissue type, developmental stage, or hormonal sensitivity, and highlights the complex interplay between auxin type, stress signaling, and antioxidant capacity. Ultimately, while NAA may support organogenic potential, 2,4-D appears more effective in priming antioxidant defenses, a distinction critical for optimizing stress resilience in vitro. Notably, AgNO₃ at 1.0 mg/L induced moderate APX responses across treatments, suggesting it can elicit antioxidant responses but may also temper the strong APX induction driven by optimal PGR combinations. Additionally, primary callus cultures consistently outperformed subcultured lines in APX activity, except for treatment 5, which maintained a relatively high response despite being subcultured. Collectively, the data indicate that the combination of BAP and 2,4-D is a key driver of antioxidant potential, with AgNO₃ modulating this effect in a context-dependent manner (Fig. 9). However, to fully disentangle the implications of APX activity—whether as a signal of stress intensity or stress resilience—additional oxidative stress markers such as H₂O₂, malondialdehyde (MDA), or total ROS quantification would be required.
AgNO₃ modulated oxidative stress in auxin-specific contexts, alleviating 2,4-D-induced stress while exacerbating NAA-mediated stress responses.
Furthermore, ethylene action inhibitors, such as AgNO₃, suppress ethylene signaling by blocking receptor function, distinguishing them from biosynthesis inhibitors that only limit endogenous ethylene production200. This receptor-level interference can reduce oxidative stress when ethylene acts as a stress amplifier, as in high-stress contexts like BAP + 2,4-D treatments, where reactive oxygen species (ROS) and ethylene engage in a positive feedback loop. However, in low-stress environments (e.g., BAP + NAA), where ethylene may serve a protective role by fine-tuning antioxidant systems, its inhibition disrupts redox balance, leading to increased stress. This duality is underpinned by ethylene’s complex interplay with other phytohormones such as JA, SA, and ABA, as well as its influence on MAPK-mediated signaling cascades that regulate antioxidant enzyme activity200. Furthermore, broader hormonal crosstalk, including the involvement of auxin, cytokinin, and brassinosteroids, adds layers of modulation to plant oxidative responses. Genetic and chemical manipulation of ethylene perception, including targeting signaling components like EIN2 and ERFs, emerges as a viable strategy for improving stress resilience, but must be applied with consideration of the plant’s baseline oxidative load and hormonal milieu.
Correlation matrix analysis revealed a largely weak and statistically non-significant association between APX activity and most measured parameters (Fig. 8B-E). APX activity showed no meaningful linear correlation with artemisinin content (r = 0.0828, p = 0.5759) or with the zone of inhibition against S. aureus (r = –0.1031, p = 0.4858). A similarly negligible relationship was observed for A. fumigatus (r = 0.0375, p = 0.8001). In contrast, a statistically significant yet modest positive correlation was detected between APX activity and the inhibition zone for P. aeruginosa (r = 0.2961, p = 0.0410), suggesting that elevated APX levels may be mildly associated with enhanced antimicrobial effects against this specific pathogen. While the strength of this association is limited, its significance implies a potential functional link worth further exploration. These findings indicate that, under the current experimental conditions, APX activity does not broadly correlate with artemisinin content or antimicrobial efficacy, but may selectively influence responses to specific microbial targets such as P. aeruginosa. Further mechanistic studies incorporating broader oxidative and enzymatic markers are warranted to elucidate the biological basis of this selective interaction.
This study was designed as a hypothesis-generating screen to identify promising elicitor and phytohormone combinations from a wide experimental matrix. While this approach successfully pinpointed key treatments for modulating the metabolism of A. annua callus, the study’s breadth necessitates specific considerations regarding the depth of its mechanistic insight. The conclusions are therefore framed within the context of these methodological boundaries, which in turn define clear priorities for future research.
The reliance on APX activity as a singular proxy for the antioxidant response provides a valuable but incomplete snapshot of the cellular redox state. A comprehensive understanding requires a multi-faceted approach, including direct quantification of reactive oxygen species (e.g., H₂O₂, O₂−•), assessment of oxidative damage markers (e.g., malondialdehyde for lipid peroxidation), and parallel activity assays for other key enzymes such as catalase and superoxide dismutase. Similarly, the interpretation of AgNO₃‘s effects is predicated on its established role as an ethylene signaling inhibitor. Disentangling its specific inhibitory function from potential off-target effects or direct ion toxicity would necessitate comparative studies using other ethylene modulators (e.g., 1-MCP, AVG) and direct measurement of ethylene evolution. A time-course analysis of these parameters would further resolve the temporal dynamics of the stress responses.
On a genetic and metabolic level, the use of heterogeneous callus tissue introduces inherent variability due to somaclonal variation. Future work aimed at creating stable, high-yielding systems would benefit from the development and characterization of clonal cell lines. The absence of transcriptomic data for artemisinin biosynthetic genes currently limits the resolution of the underlying regulatory networks; linking the observed metabolic shifts to the expression levels of key pathway genes (e.g., ADS, DBR2) and transcription factors is a critical next step. The observed weak correlation between antioxidant and antimicrobial profiles also points toward the need for untargeted metabolomics to identify the specific non-antioxidant compounds responsible for the potent bioactivity.
Ultimately, moving from the empirical patterns identified here to predictive and scalable applications demands the integration of multi-omics strategies. Combining transcriptomics, proteomics, and metabolomics is crucial for elucidating the complex crosstalk between hormonal signals, stress responses, and metabolic pathways. The insights gained can then inform the rational design of elicitation protocols for optimized production in controlled bioreactor systems, with subsequent preclinical evaluation of extract bioavailability and pharmacokinetics essential for any translational development into phytopharmaceutical applications (Fig. 10).
toward enhanced phytochemical production. The schematic outlines two divergent pathways for the biotechnological application of Artemisia annua L. callus cultures, designed to achieve distinct metabolic outcomes. Pathway 1 is geared towards generating a complex mixture of diverse phytochemicals for use in functional foods or nutraceuticals. This strategy utilizes different elicitation protocols to induce a broad-spectrum stress response, leading to the accumulation of various classes of bioactive compounds. Pathway 2 is optimized for maximizing biomass and enhancing the production of the target antimalarial compound, artemisinin. This approach employs specific combinations of plant growth regulators (PGRs) and elicitors intended to upregulate the artemisinin biosynthetic pathway. This framework provides a model for rationally designing cell culture protocols based on the desired end-product.
In conclusion, this study demonstrates that A. annua callus cultures provide a robust platform for dissecting stress physiology and that specific combinations of plant growth regulators and elicitors can be strategically leveraged to enhance biomass and modulate metabolic output. The combination of 5 mg/L BAP and 1 mg/L NAA was identified as optimal for callus proliferation, with elicitation by AgNO₃ significantly boosting biomass, acting as a potent but general stress elicitor with limited targeted influence on artemisinin biosynthesis. The findings underscore that the observed phenotypic and metabolic outcomes are downstream consequences of chemically induced stress. The extracts demonstrated variable antimicrobial activity, with Staphylococcus aureus exhibiting the highest susceptibility (or ‘strongest growth inhibition’). The paradoxical stress adaptation elicited by certain auxin–cytokinin combinations highlights the nuanced, and at times counterintuitive, crosstalk between hormonal and oxidative signaling networks. Ultimately, this work establishes a comprehensive profile of elicitor-induced effects and provides a validated framework for the scalable production of high-value phytochemicals, setting the stage for future mechanistic studies to dissect the precise signaling cascades coupling stress to metabolism in this vital medicinal plant.
Methods
Reagents and materials
Plant materials, including seeds and wild Artemisia annua L. plants, were provided by Dr. Mamta Ghokale, founder and director of SHRIM BIO INNOVATION & RESEARCH, Jabalpur, MP, India, where the tissue culture work was conducted (Supplementary Fig. 9). The plant materials were sourced with approval from the Tropical Forest Research Institute (TFRI), Jabalpur, MP, India. Murashige and Skoog (1962) basal medium (composition provided in Supplementary Table 2) was used for plant tissue culture. All chemicals for MS media preparation were procured from Hi-Media Laboratories Pvt. Ltd., India. For antimicrobial studies, Mueller-Hinton Agar (REF: M173-500G) and Peptone Water (REF: M028-500G) were purchased from Hi-Media Laboratories Pvt. Ltd., India. Agar-Agar (Bacteriological grade; Catalog: A0210; Batch No: J118D23) was obtained from RANKEM, Maharashtra, India. Dextrose Monohydrate was sourced from Loba Chemie PVT. LTD., India. The antibiotic Ciprofloxacin and antifungal drug Itraconazole were obtained from Sigma, India. The analytical grade standard for artemisinin (69532-10MG; CAS-No: 63968-64-9) was procured from Sigma, India. Solvents, including Hexane and Ethanol, were purchased from Qualigens, Thermo Fisher Scientific, Mumbai, India Pvt. Ltd. Buffer components included Potassium Dihydrogen OrthoPhosphate (KH₂PO₄), sourced from Qualigens, Thermo Fisher Scientific, Mumbai, India Pvt. Ltd., and Di-Potassium Hydrogen Orthophosphate (K₂HPO₄), obtained from Central Drug House (CDH) (P) LTD, Bombay, India. Hydrogen Peroxide Solution (30% w/v H₂O₂) was purchased from Qualigens, Thermo Fisher Scientific, Mumbai, India Pvt. Ltd. Ascorbic acid (Batch No: N059H22) was procured from RANKEM, Maharashtra, India. Additionally, 0.2 µm, 13 mm Nylon disposable syringe filters (Cat No: SFNY13RB) were obtained from AXIVA Sichem Biotech, India.
Explant surface sterilization
To ensure aseptic conditions for tissue culture experiments, all materials, including glassware, utensils, chemicals, culture medium, plant growth regulators, and explants, were sterilized before use (Supplementary Fig. 6). Heat-resistant glassware, tools, and medium were autoclaved at 121 °C and 15 psi for 20 minutes. All work surfaces, both within and surrounding the laminar flow hood, were disinfected with 70% (v/v) ethanol. Subsequently, the enclosed working area of the laminar hood itself was sterilized by exposure to UV light for 30 minutes before initiating the procedure. Leaf explants were first washed by soaking in 1% (v/v) Labolene (a non-toxic wetting agent) for 6 minutes, followed by thorough rinsing under running tap water. The explants were then rinsed three times with double-distilled water (DDW) to remove detergent residues. For surface sterilization, explants were immersed in 70% ethanol for 2 minutes, followed by three additional rinses in sterile DDW under a laminar hood. Finally, they were treated with 0.1% (w/v) mercuric chloride (HgCl₂) for 2 minutes and thoroughly rinsed three times in sterile DDW to eliminate traces of the sterilant.
Establishment of in vitro culture of A. annua
Young, healthy leaves of A annua were excised and surface sterilized to eliminate microbial contaminants as mentioned above. Sterilized leaves were aseptically dissected into appropriate explant sizes using a sterile scalpel and forceps under a laminar airflow cabinet. The Murashige and Skoog (MS) medium was prepared with 0.8% (w/v) agar (Hi-Media Laboratories Pvt. Ltd., Mumbai, India) and autoclaved at 121 °C (15 psi) for 20 minutes. The medium was allowed to solidify in the laminar flow hood prior to use. The explants were then inoculated onto semi-solid MS medium supplemented with various concentrations of plant growth regulators (PGRs), including 6-benzylaminopurine (BAP), kinetin (KN), 2,4-dichlorophenoxyacetic acid (2,4-D), and 1-naphthaleneacetic acid (NAA), for optimized growth and organogenesis.
The cultures were maintained in sterile culture tubes (25 × 150 mm) and 250 mL conical flasks, ensuring proper aeration and nutrient availability. All cultures were incubated in a controlled growth chamber at 25 ± 2 °C, with a relative humidity (RH) of 60–70% and a light intensity of ~20 µmol m−2 s−1 PPFD (Photosynthetic Photon Flux Density), provided by cool white fluorescent tubes (Supplementary Fig. 10). A 16/8-hour light/dark photoperiod was maintained to support optimal in vitro growth.
Callus induction
Callus induction was performed on Murashige and Skoog (MS) medium supplemented with individual or a combination of plant growth regulators (PGRs): 6-benzylaminopurine (BAP), kinetin (KN), 1-naphthaleneacetic acid (NAA), and 2,4-dichlorophenoxyacetic acid (2,4-D), as outlined in Table 4. The experimental design consisted of thirteen treatments with three replicates per treatment (Fig. 11). The experiment was conducted for 6 weeks, during which callogenesis was observed and systematically recorded. At the end of the culture period, callus morphology was evaluated based on texture and proliferation intensity. The key parameters assessed included: (i) callus formation (presence or absence), (ii) proliferation intensity (categorized as high, moderate, or low), (iii) callus color (green, pale green, yellow, pale yellow, or brown), (iv) texture (friable, non-friable, or compact), and (v) fresh and dry weight measurements. Observations were recorded at regular intervals to ensure accurate monitoring of callus development and response to PGR treatments.
Leaf explants were harvested and used for tissue culture experiments. A total of thirteen different treatments were evaluated for their efficacy in callus induction. Based on their superior performance, three treatments—designated as F, G, and L—were selected for further experimentation. To confirm reproducibility, a fresh batch of callus cultures was induced using treatments F, G, and L. For each treatment, fifteen replicates were prepared (twelve primary replicates plus three additional ones to account for potential contamination or culture damage). Three replicates per treatment were designated for callus induction validation, while the remaining replicates were allocated for the elicitation experiment involving AgNO₃ (only in Group 2). For the elicitation experiment, three replicates of callus cultures derived from each selected treatment (F, G, and L) were subcultured on Murashige and Skoog (MS) medium supplemented with the corresponding plant growth regulators and AgNO₃ at concentrations of 0.5 mg/L, 1.0 mg/L, or 2.0 mg/L. Simultaneously, an additional set of three replicates per treatment was prepared in MS medium supplemented with the corresponding plant growth regulators and 1.0 mg/L AgNO₃. In this setup, surface-sterilized fresh leaf explants were inoculated and incubated in the culture room under controlled conditions. Key: Thick dark arrows represent transitions between different types of experiments, while thick dark-blue arrows indicate stepwise progression within and between experimental stages. Solid dark arrows show sequential transitions between processes within a single experiment. Bipolar red dotted arrows denote exceptional or non-standard transitions across steps or experiments.
Callus texture was determined through visual inspection and tactile evaluation, and classified into three categories: (1) friable—exhibiting a loose, granular, and easily crumbled structure [ideal for cell suspension cultures and genetic transformation]; (2) non-friable—semi-soft and cohesive but resistant to disintegration [suitable for cell suspension cultures following the application of mechanical/enzymatic treatment]; or (3) compact—characterized by a dense, nodular, and firm consistency [often indicative of organogenic potential or differentiation]. Proliferation intensity was assessed relative to the size of the original explant: Low (+) indicated limited growth (<50% coverage), Moderate (++) denoted moderate growth (~50–75% coverage), and High (+++) represented vigorous growth (>75% coverage). Representative images of distinct callus textures are shown in Supplementary Fig. 17.
Elicitation
Elicitation experiments were conducted using two distinct approaches: callus-based elicitation and direct leaf explant elicitation. In the callus-based approach, callus tissues derived from treatments that successfully induced callogenesis were subcultured onto the respective callus induction medium supplemented with varying concentrations of silver nitrate (AgNO₃) at 0.5, 1, and 2 mg/L (Table 5). In the direct leaf explant approach, leaf explants were inoculated onto Murashige and Skoog (MS) medium containing the previously identified effective callus induction treatments, supplemented with 1 mg/L AgNO₃. Both elicitation experiments were maintained under controlled environmental conditions (same as those used above for induction) for 6 weeks. During this period, key parameters—including fresh and dry callus weight, artemisinin content, bioactivity, and antioxidant activity of the callus extracts—were systematically measured and recorded to assess the impact of elicitation.
Phytochemical profiling and analysis
Crude extracts obtained from the samples were subjected to HPLC for the quantification of artemisinin content and GC-MS for phytochemical profiling to determine the chemical constituents of selected sample extracts.
Crude extracts were prepared for subsequent phytochemical analysis. Freshly harvested samples were weighed on a high-precision balance (Mettler Toledo, ME204) to determine the initial fresh weight (W₅, g). The samples were then dried in a hot air oven (GENTEK Pvt. Ltd, India) at 50 ± 3 °C for 24 hours, after which the final dry weight (W₄, g) was recorded. The dried material was finely ground using a mortar and pestle. For extraction, the resulting powder was macerated in n-hexane at a 1:50 (w/v) ratio, followed by continuous agitation at 125 RPM for 48 hours at room temperature on a rotary flask shaker (ICON INSTRUMENTS COMPANY, Delhi, India), according to a modified protocol by Erdemoğlu et al.201. After maceration, the solid residue was removed by filtration. The n-hexane filtrate was then concentrated in a hot air oven at 50 ± 3 °C, and a 2 mL aliquot of the resulting crude extract was transferred to a pre-weighed Eppendorf tube and evaporated to complete dryness.
The final weight of the dried crude extract (a₃, g) was determined gravimetrically. The percentage yield was calculated relative to the initial dry sample weight using the formula: % Yield = (a₃/W₄) × 100 (Fig. 12). The key weights were derived as follows: fresh sample weight (W₅, g) and dried sample weight (W₄, g) were determined by subtracting the weight of the petri dish from the total weight before and after drying, respectively. The final extract weight (a₃, g) was determined by subtracting the weight of the empty Eppendorf tube. The resulting crude extracts were then subjected to HPLC for artemisinin quantification and GC-MS for comprehensive phytochemical profiling.
Phase I: Test tube samples were weighed and recorded. Fresh leaf samples were prepared in triplicate, with each replicate weighing 1.5 g. Phase II: The weighed samples were oven-dried at ~52 °C for 24 hours. Phase III: Fully dried samples were ground into a fine powder using a mortar and pestle. Phase IV: The powdered samples were transferred into glass vessels, and n-hexane was added based on their predetermined dry weight. The samples were then placed in a shaker and mixed for 48 hours. After mixing, the contents were filtered to remove debris, and the clear solvent was evaporated in an oven at 52 °C to eliminate residual n-hexane. Phase V: Approximately 1.5 ml of the extracted samples was transferred into 2-ml aliquot tubes. After oven drying at 52 °C, the dry extract was obtained, and its weight was recorded. Phase VI: The device was calibrated using a standard artemisinin solution for HPLC analysis of artemisinin content. The dried sample extracts were then re-suspended in 70% ethanol, filtered, and prepared for HPLC analysis.
The key notations used in the study are as follows: W₁ represents the weight of the fresh sample along with the Petri dish (in grams), while W₂ denotes the weight of the empty Petri dish (in grams). W₃ is the weight of the dried sample together with the Petri dish (in grams). From these, W₄, the dried sample weight, is calculated, and W₅ refers to the fresh sample weight, both expressed in grams. Additionally, a₁ is the weight of the empty Eppendorf tube (in grams), a₂ is the weight of the dried extract along with the Eppendorf tube (in grams), and a₃ indicates the extract dry weight (in grams).
For HPLC analysis, the mobile phase, consisting of acetonitrile and water (65:35, v/v), was degassed via sonication and sparged with helium. A stock solution of artemisinin (1 mg/mL in ethanol) was used to prepare working standards for a three-point calibration curve at concentrations of 800, 900, and 1000 µg/mL. Sample extracts were dissolved in ethanol (5 mg/mL), sonicated, and filtered through a 0.2 µm PTFE membrane before injection.
Chromatographic separation was performed on an Agilent G4288C 1220 Infinity II Gradient LC System (Agilent, USA) equipped with an Agilent TC-C18(2) column (4.6 × 250 mm, 5 µm). Isocratic elution was performed with acetonitrile:water (65:35, v/v) at a flow rate of 1.5 mL/min. The injection volume was 20 µL, the column temperature was maintained at 25 °C, and detection was performed at 210 nm over a 15-minute run time (Supplementary Table 4).
The specific calibration range was selected due to a high instrumental limit of detection (LOD), estimated at ~100 µg/mL, which required high concentrations to generate reproducible peaks well above the baseline. Linearity of the standard curve was confirmed with a coefficient of determination (R²) of 0.9935202. Artemisinin concentrations in the samples, which were below the lowest standard but above the LOD, were quantified by linear extrapolation. System suitability tests were performed to ensure method reliability, monitoring retention time, theoretical plates (>2000), and tailing factor (<2.0)203. Data were analyzed using OpenLab CDS2 software, with artemisinin concentrations reported in µg/mL.
GC-MS analysis
Crude sample extracts were prepared for analysis by dissolving them in high-purity methanol to a final concentration of 1 mg/mL. Each sample solution was vortexed for 1 minute and sonicated in an ultrasonic bath for 10 minutes to ensure complete dissolution. Before injection, the solutions were clarified by filtration through a 0.22 µm polytetrafluoroethylene (PTFE) membrane filter.
Analysis was performed on a Shimadzu GC-MS QP2010 system equipped with an autosampler.
-
Gas Chromatography (GC): Chromatographic separation was achieved using an SH-I-5Sil MS capillary column (30 m × 0.25 mm internal diameter, 0.25 µm film thickness). Helium was used as the carrier gas at a constant linear velocity of 1 mL/min. A 2 µL aliquot of the sample was injected in splitless mode. The oven temperature program was initiated at 45 °C (held for 2 minutes), ramped at 5 °C/min to 140 °C (held for 2 minutes), and subsequently ramped at 10 °C/min to 280 °C (held for 10 minutes). The total run time was 52 minutes.
-
Mass Spectrometry (MS): The mass spectrometer was operated in electron ionization (EI) mode at 70 eV. The ion source and interface temperatures were maintained at 230 °C and 280 °C, respectively. Data were acquired in full-scan mode over a mass-to-charge (m/z) range of 50–500, with a scan acquisition rate of 0.5 seconds/scan. The detector voltage was set to 1.2 kV.
Data acquisition and processing were performed using Shimadzu GC-MS Solution software. Putative identification of chemical constituents was achieved by comparing the experimentally obtained mass spectra against the National Institute of Standards and Technology (NIST) 2014 Mass Spectral Library (NIST14.L). A compound was considered putatively identified if its mass spectrum exhibited a match factor of >80% with a library spectrum and its retention time was consistent with library data.
To enable meaningful cross-sample comparisons, all identified compounds were first screened to generate a refined dataset comprising the most consistently detected analytes (Supplementary Tables 5 - 11). Based on this curated set, a semi-quantitative analysis was conducted using the integrated peak area of each compound. Sample 1, which exhibited the most complete and representative chemical profile, was designated as the experimental control for comparative analysis.
Relative abundances in test samples (Samples 5, 7, 9, and 16) were calculated as fold changes by normalizing the peak area of each compound to its corresponding value in the control sample, following the formula:
Fold Change = Peak Area in Test Sample / Peak Area in Control Sample.
Compounds that were not detected in a given sample were marked as undetected (‘–’), enabling clear interpretation of presence/absence trends alongside quantitative shifts.
To ensure data quality and system stability, a standard compound mixture was analyzed for system suitability before the sample sequence. Methanol blanks were injected periodically between samples to monitor for carryover and contamination. Each sample was analyzed in triplicate to ensure analytical reproducibility.
Antimicrobial activity
The antimicrobial activity of crude extracts was assessed against three reference microbial strains obtained from Cytogene (Lucknow, India): Staphylococcus aureus (ATCC® 25923™, Gram-positive), Pseudomonas aeruginosa (ATCC® 27853™, Gram-negative), and Aspergillus fumigatus (ATCC® 204305™, filamentous fungus). Strains were maintained and quality-controlled following CLSI guidelines (M07-A11 for bacteria; M38-A2 for fungi), with their identities verified through morphological and biochemical characterization before testing.
Mueller-Hinton Agar (MHA) was prepared by weighing 17.50 g of acid hydrolysate of casein, 2.00 g of yeast extract, 1.50 g of starch, and 17.00 g of agar, which were suspended in 1000 mL of distilled water (Fig. 13). The mixture was stirred continuously and heated until all components were fully dissolved. The medium was sterilized by autoclaving at 121 °C for 15 minutes at 15 psi (GENTEK India Double Wall Vertical Autoclave). Following sterilization, it was cooled to 45–50 °C, and the pH was adjusted to 7.3 ± 0.1 using 1 N NaOH or 1 N HCl as required. The medium was then aseptically poured into sterile Petri plates inside a laminar airflow hood and left to solidify at room temperature before use.
Phase VII: Preparation of reagents for ascorbate antioxidant activity measurement across all sixteen samples. Blank and sample cuvettes were properly prepared and placed in a UV-spectrophotometer. After background activity was removed using the blank sample, the antioxidant activity of all sixteen samples was determined spectrophotometrically. The absorbance values were recorded and used to calculate the activity based on a standard curve. Phase VIII: Bacterial and fungal growth media components were weighed and prepared. Media components were mixed in a glass vessel with the appropriate amount of water. Petri plates, pipette tips, and aliquot tubes were washed, oven-dried, sealed in paper, and autoclaved at 120 °C for 30 minutes. The autoclaved items were then cooled and transferred to the laminar flow chamber. Phase IX: Microbial strains (S. aureus, P. aeruginosa, and A. fumigatus) were obtained from the Cytogene culture collection and re-suspended in the appropriate solvent or medium. Phase X: Microbial cultures and sample extracts were placed in the laminar chamber. The microorganisms were spread onto the solid medium of each Petri plate according to the experimental category (antibacterial or antifungal). Five wells were created per plate: three for the triplicate sample extracts, one for the negative control, and one for the positive control. Phase XI: Approximately 0.5 mL of each extract was transferred into the designated wells on each Petri plate. n-hexane was the negative control, while an antibiotic was the positive control. Phase XII: Plates were incubated at 28 °C for 24–72 hours, depending on the microorganism. The inhibition zones were documented using an imaging or documentation system, measured with a calliper, and recorded.
Sabouraud dextrose agar (SDA) was prepared by dissolving 10.0 g of peptone, 40.0 g of dextrose, and 15.00 g of agar in 1000 mL of distilled water with continuous stirring until complete dissolution was achieved. The medium was sterilized by autoclaving at 121 °C for 15 minutes at 15 psi (GENTEK India Double Wall Vertical Autoclave). After sterilization, it was cooled to 45–50 °C, and the pH was adjusted to 5.6 ± 0.2 using 1 N NaOH or 1 N HCl as needed. The sterilized medium was then dispensed into sterile Petri plates (10 cm×1.5 cm) under aseptic conditions in a laminar airflow hood and allowed to solidify at room temperature before use (Fig. 13).
The antibacterial activity of sixteen crude extract samples was evaluated against Staphylococcus aureus (ATCC 25923) and Pseudomonas aeruginosa (ATCC 27853) using the well-diffusion method. Bacterial cultures were grown overnight in nutrient broth at 37 °C, and the inoculum was adjusted to 0.5 McFarland standard (~1–2 × 10⁸ CFU/mL) before evenly spreading 100 µL on the MHA plates using a sterile cotton swab. After allowing the plates to dry for 10 minutes, five uniformly spaced wells (6 mm in diameter, with a minimum inter-well distance of 25 mm to prevent overlapping inhibition zones) were aseptically created using a sterile cork borer. Three wells were each loaded with 20 µL of the test samples, while the fourth and fifth wells served as controls, receiving 15 µL of ciprofloxacin (100 ppm) as a positive control and 20 µL of n-hexane as a negative control, respectively. The plates were maintained at 25 ± 2 °C for 30 minutes to allow diffusion of the samples into the medium before incubation. Plates were sealed with paraffin film and incubated at 37 °C for 24 hours. The diameter of the zones (cm) of inhibition was measured using a digital calliper (Fig. 5). Each sample was tested in triplicate, and antibacterial activity was expressed as the mean inhibition zone diameter ± standard deviation, compared to the positive and negative controls to determine efficacy.
The antifungal activity of sixteen crude extract samples was evaluated against Aspergillus fumigatus (ATCC 204305) using the well-diffusion method. A standardized fungal inoculum (1 × 10⁶ spores/mL) was prepared by harvesting spores from a 7-day-old culture and resuspending them in sterile saline. The spore concentration was determined using a hemocytometer to ensure accuracy. A 100 µL aliquot of the inoculum was evenly spread onto the surface of SDA plates using a sterile cotton swab and allowed to dry for 10 minutes under aseptic conditions. Wells (6 mm in diameter) were aseptically punched using a sterile cork borer, ensuring uniform spacing to prevent overlapping inhibition zones. Each plate contained five wells: three wells were loaded with 20 µL of test samples, while the fourth and fifth wells served as positive (15 µL of Itraconazole, 350 ppm) and negative (20 µL of n-hexane) controls, respectively. The plates were sealed with parafilm to prevent contamination and incubated at 25 °C for 24–48 hours. Following incubation, the diameters of inhibition zones (cm) were measured using a digital calliper (Fig. 5). Each sample was tested in triplicate, and antifungal activity was expressed as the mean inhibition zone diameter ± standard deviation, compared to the positive and negative controls to determine efficacy.
MIC assay
The MIC of the test sample was determined using a tube dilution method. For bacterial assays against Pseudomonas aeruginosa (ATCC 27853) and Staphylococcus aureus (ATCC 25923), Nutrient Broth (NB) was prepared by dissolving yeast extract (3.00 g), peptone (5.00 g), and sodium chloride (5.00 g) in 1000 mL of distilled water and adjusting the pH to 7.0 ± 0.2. For the fungal assay against Aspergillus fumigatus, Sabouraud Dextrose (SD) Broth was prepared with peptone (10.0 g) and dextrose (40.0 g) in 1000 mL of distilled water, with the pH adjusted to 5.6 ± 0.2. Both media were autoclaved at 121 °C for 15 minutes. Bacterial inocula were prepared from 24-hour-old cultures adjusted to a 0.5 McFarland standard (~1 × 10⁸ CFU/mL), while fungal inocula were prepared from 48-hour-old cultures adjusted to 1 × 10⁶ spores/mL using a hemocytometer. A stock solution of the test sample (50 mg/mL) was prepared in n-hexane, and serial dilutions were performed in the appropriate broth to achieve final assay concentrations ranging from 50 mg/mL to 0.098 mg/mL.
The assay was conducted in test tubes, each containing 1 mL of broth with the designated sample concentration. To each tube, 50 μL of the prepared bacterial or fungal inoculum was added. A set of controls was included in triplicate for each assay: a sterility control (broth only), a growth control (broth + inoculum), and a positive control (broth + inoculum + either 0.1 mg/mL ciprofloxacin for bacteria or 0.35 mg/mL itraconazole for fungi). The inoculated tubes for bacterial assays were incubated statically at 37 °C for 24 hours, while fungal assays were incubated at 25 °C for 48 hours.
Following incubation, microbial growth was assessed by visual inspection for turbidity and by measuring the optical density (OD) at 680 nm using a PC-based double-beam UV-VIS Spectrophotometer (Model 2201). The MIC was determined as the lowest concentration at which no turbidity was observed and the OD remained < 0.1, following CLSI (2018) guidelines204. All assays were performed in triplicate to ensure reproducibility.
Quantification of APX activity
APX remains a uniquely informative biomarker—mechanistically relevant, spatially integrated, and functionally central. Therefore, for this initial high-throughput screening study, APX activity was used as a primary and sensitive proxy for oxidative stress adaptation in A. annua callus cultures subjected to various plant growth regulator (PGR) combinations and silver nitrate (AgNO₃) elicitation (Figs. 1 and 2).
APX activity was determined by monitoring the rate of hydrogen peroxide (H₂O₂)-dependent ascorbate oxidation via the decrease in absorbance at 290 nm, following a modified method of Nakano and Asada (1981)190,205,206. Enzyme activity was calculated based on the rate of ascorbate oxidation, using a molar extinction coefficient of 2.8 mM−1 cm−1.
The reaction was conducted in a 2 mL total volume within a 1 cm quartz cuvette. The assay mixture comprised 660 µL of 50 mM potassium phosphate buffer (pH 7.0), 660 µL of 0.5 mM ascorbate, and 20 µL of crude plant extract. The components were added sequentially and pre-mixed on ice. After establishing a baseline absorbance reading, the reaction was initiated with the final addition of 660 µL of 0.5 mM H₂O₂. The decrease in absorbance at 290 nm was immediately recorded every 10 seconds for 3 minutes using a UV/Vis spectrophotometer (Systronics, model 2202).
Calculation of Enzyme Activity: One unit (U) of APX activity was defined as the amount of enzyme required to consume 1 µmol of ascorbate per minute under the specified assay conditions. The activity was calculated using the formula:
Activity (U/mL) = [ΔA290 × Vt × dilution factor] / [T × ϵ × l × Vs]
Where: ΔA290 is the change in absorbance at 290 nm measured over 3 minutes (Initial OD – Final OD), Vt is the total reaction volume (2 mL), DF is Dilution factor (1000), T is the time interval of measurement (3 minutes), ϵ is the molar extinction coefficient (2.8 mM−1 cm−1), l is the path length (1 cm), and Vs is the volume of the enzyme extract (0.02 mL). APX activity was expressed as micromoles of ascorbate oxidized per minute per gram of fresh weight (µmol min−1 g−1 FW).
All measurements were performed in triplicate. To ensure data accuracy and specificity, each experimental run included: (i) a blank reaction (without plant extract) to correct for non-enzymatic H₂O₂-mediated ascorbate oxidation, (ii) a negative control (without H₂O₂) to confirm the reaction’s dependency on the substrate, and (iii) a known APX-positive control to verify system suitability. All buffers and solutions were prepared using high-purity water (Millipore) and stored at 4 °C, then equilibrated to room temperature before use.
Statistical analysis
All tissue culture experiments were conducted using a completely randomized design. Explants, either leaf sections or callus subcultures, were randomly assigned to treatment groups using a random number generator. Each treatment consisted of three biological replicates (n = 3). After 6 weeks of incubation, key response variables, including callus fresh and dry weights, were recorded for statistical analysis.
All statistical analyses were performed in RStudio (version 4.4.0). Before analysis, datasets were assessed for normality and homogeneity of variance using the Shapiro-Wilk test and Levene’s test, respectively.
-
For normally distributed data (p ≥ 0.05) with homogeneous variances, a one-way analysis of variance (ANOVA) was used to compare treatment groups. Significant differences between means were then identified using Tukey’s Honestly Significant Difference (HSD) post-hoc test.
-
If data violated normality assumptions, the non-parametric Kruskal–Wallis test was applied, followed by Dunn’s test with a Bonferroni correction for pairwise comparisons.
For all tests, statistical significance was set at p < 0.05. Results are expressed as mean ± standard error (SE) for parametric data or median ± interquartile range (IQR) for non-parametric data. Significant differences between groups are indicated in the figures by distinct letters (e.g., a, b, c).
Data availability
All data generated or analysed during this study are included in this published article and its supplementary data/information files. The GC-MS raw files dataset is freely accessible at Zenodo.org as (10.5281/zenodo.15428029). For any further queries, primary correspondence should be addressed to Dexter Achu Mosoh.
References
Herrmann, L. et al. Synthesis and in vitro study of artemisinin/synthetic peroxide-based hybrid compounds against SARS-CoV-2 and cancer. ChemMedChem 17, e202200005 (2022).
Herrmann, L. et al. Access to artemisinin–triazole antimalarials via organo-click reaction: high in vitro/in vivo activity against multi-drug-resistant malaria parasites. JACS Au 4, 951–957 (2024).
Su, X.-Z. & Miller, L. H. The discovery of artemisinin and the nobel prize in physiology or medicine. Sci. China Life Sci. 58, 1175–1179 (2015).
Badshah, S. L., Ullah, A., Ahmad, N., Almarhoon, Z. M. & Mabkhot, Y. Increasing the strength and production of artemisinin and its derivatives. Molecules 23, 100 (2018).
Brisibe, E. A. et al. Nutritional characterisation and antioxidant capacity of different tissues of Artemisia annua. L. Food Chem. 115, 1240–1246 (2009).
Sarkar, D., Monzote, L., Gille, L. & Chatterjee, M. Natural endoperoxides as promising anti-leishmanials. Phytomedicine 129, 155640 (2024).
Qamar, F., Ashrafi, K., Singh, A., Dash, P. K. & Abdin, M. Z. Artemisinin production strategies for industrial scale: current progress and future directions. Ind. Crops Prod. 218, 118937 (2024).
Carrà, A., Bagnati, R., Fanelli, R. & Bonati, M. Fast and reliable artemisinin determination from different Artemisia annua leaves based alimentary products by high performance liquid chromatography–tandem mass spectrometry. Food Chem. 142, 114–120 (2014).
Fu, C., Yu, P., Wang, M. & Qiu, F. Phytochemical analysis and geographic assessment of flavonoids, coumarins and sesquiterpenes in Artemisia annua L. based on HPLC-DAD quantification and LC-ESI-QTOF-MS/MS confirmation. Food Chem. 312, 126070 (2020).
Melillo De Magalhães, P. et al. Anti-inflammatory effect and modulation of cytochrome P450 activities by Artemisia annua tea infusions in human intestinal Caco-2 cells. Food Chem. 134, 864–871 (2012).
Shigeoka, S. et al. Regulation and function of ascorbate peroxidase isoenzymes. J. Exp. Bot. 53, 1305–1319 (2002).
Sofo, A., Scopa, A., Nuzzaci, M. & Vitti, A. Ascorbate peroxidase and catalase activities and their genetic regulation in plants subjected to drought and salinity stresses. Int. J. Mol. Sci. 16, 13561–13578 (2015).
Anjitha, K. S., Sameena, P. P. & Puthur, J. T. Functional aspects of plant secondary metabolites in metal stress tolerance and their importance in pharmacology. Plant Stress 2, 100038 (2021).
Kumari, A. et al. ROS regulation mechanism for mitigation of abiotic stress in plants. In Reactive Oxygen Species (IntechOpen, 2021). https://doi.org/10.5772/intechopen.99845.
Tanwir, K. et al. Chapter 32 - Antioxidant defense systems in bioremediation of organic pollutants. in Handbook of Bioremediation (eds. Hasanuzzaman, M. & Prasad, M. N. V.) 505–521 (Academic Press, 2021).
Mosoh, D. A., Khandel, A. K., Verma, S. K. & Vendrame, W. A. Phytochemical analysis and enhanced production of alkaloids in non-dormant corm-derived callus of Gloriosa superba (L.) using plant growth regulators and abiotic elicitors. Plant Cell Tissue Organ Cult.156, 89 (2024).
Afzal, F., Khurshid, R., Ashraf, M. & Gul Kazi, A. Chapter 13 - reactive oxygen species and antioxidants in response to pathogens and wounding. In Oxidative Damage to Plants (ed. Ahmad, P.) 397–424 (Academic Press, San Diego, 2014).
Mosoh, D. A. Plant growth regulator studies and emerging biotechnological approaches in Artemisia annua L.: a comprehensive overview. South Afr. J. Bot. 181, 181–222 (2025).
Li, Y. et al. Advanced metabolic engineering strategies for increasing artemisinin yield in Artemisia annua. L. Hortic. Res. 11, uhad292 (2024).
Tang, Y. et al. AaEIN3 mediates the downregulation of artemisinin biosynthesis by ethylene signaling through promoting leaf senescence in Artemisia annua. Front. Plant Sci. 9, 413 (2018).
Lu, X. et al. Promotion of artemisinin biosynthesis in transgenic Artemisia annua by overexpressing ADS, CYP71AV1 and CPR genes. Ind. Crops Prod. 49, 380–385 (2013).
Yang, R.-Y. et al. SenesCent Leaves Of Artemisia Annua Are One Of The Most Active Organs For Overexpression Of Artemisinin Biosynthesis Responsible Genes Upon Burst Of Singlet Oxygen. Planta Med. 76, 734–742 (2009).
Pehlivan Karakas, F., Sahin, G., Ucar Turker, A. & Verma, S. K. Impacts of heavy metal, high temperature, and UV radiation exposures on Bellis perennis L. (common daisy): comparison of phenolic constituents and antioxidant potential (enzymatic and non-enzymatic). South Afr. J. Bot. 147, 370–379 (2022).
Elazab, D., Lambardi, M. & Capuana, M. In vitro culture studies for the mitigation of heavy metal stress in plants. Plants 12, 3387 (2023).
Cañizares, E. et al. Interplay between secondary metabolites and plant hormones in silver nitrate-elicited Arabidopsis thaliana plants. Plant Physiol. Biochem. 208, 108483 (2024).
Huchzermeyer, B., Menghani, E., Khardia, P. & Shilu, A. Metabolic pathway of natural antioxidants, antioxidant enzymes and ROS providence. Antioxidants 11, 761 (2022).
Kruszka, D. et al. Silver nanoparticles affect phenolic and phytoalexin composition of Arabidopsis thaliana. Sci. Total Environ. 716, 135361 (2020).
Selvakesavan, R. K., Kruszka, D., Shakya, P., Mondal, D. & Franklin, G. Impact of Nanomaterials on Plant Secondary Metabolism. In Nanomaterial Interactions with Plant Cellular Mechanisms and Macromolecules and Agricultural Implications (eds. Al-Khayri, J. M., Alnaddaf, L. M. & Jain, S. M.) 133–170 (Springer International Publishing, Cham, 2023).
Iqbal, M. et al. Silver nanoparticles and silver salt (AgNO3) elicits morphogenic and biochemical variations in callus cultures of sugarcane. IET Nanobiotechnol. 13, 896–904 (2019).
Ali, A. et al. Silver nanoparticles elicited in vitro callus cultures for accumulation of biomass and secondary metabolites in Caralluma tuberculata. Artif. Cells Nanomed. Biotechnol. 47, 715–724 (2019).
Maqbool, M. et al. Enhancing bioactive metabolite production in aerva sanguinolenta callus cultures through silver nanoparticle and salicylic acid elicitation. Sustainability 15, 10395 (2023).
Bakr, Z., Said, S. M., Mohammad, W. A., Aboulnasr, G. N. & Elshimy, N. A. Silver-nanoparticle- and silver-nitrate-induced antioxidant disbalance, molecular damage, and histochemical change on the land slug (lehmannia nyctelia) using multibiomarkers. Front. Physiol. 13, 945776 (2022).
Ghanati, F. & Bakhtiarian, S. Changes of natural compounds of Artemisia annua L. by methyl jasmonate and silver nanoparticles. Adv. Environ. Biol. 7, 2251–2259 (2013).
Zhang, B. et al. Stimulation of artemisinin production in Artemisia annua hairy roots by Ag-SiO2 core-shell nanoparticles. Curr. Nanosci. 9, 363–370 (2013).
Adoni, M., Yadam, M., Gaddam, S. A., Rayalacheruvu, U. & Kotakadi, V. S. Antimicrobial, antioxidant, and dye degradation properties of biosynthesized silver nanoparticles from Artemisia annua L. Lett. Appl. NanoBioScience 10, 1981–1992 (2020).
Basavegowda, N., Idhayadhulla, A. & Lee, Y. R. Preparation of Au and Ag nanoparticles using Artemisia annua and their in vitro antibacterial and tyrosinase inhibitory activities. Mater. Sci. Eng. C. 43, 58–64 (2014).
Bohdanovych, T. et al. Comparison of silver and gold nanoparticles green synthesis by Artemisia annua hairy root extracts. Biol. Open 14, bio061739 (2025).
Khatoon, N., Ahmad, R. & Sardar, M. Robust and fluorescent silver nanoparticles using Artemisia annua: Biosynthesis, characterization and antibacterial activity. Biochem. Eng. J. 102, 91–97 (2015).
Xia, P.-F. et al. GroE chaperonins assisted functional expression of bacterial enzymes in Saccharomyces cerevisiae. Biotechnol. Bioeng. 113, 2149–2155 (2016).
Ali, M. et al. Inhibition of phytophthora parasitica and P. capsici by silver nanoparticles synthesized using aqueous extract of Artemisia absinthium. Phytopathology 105, 1183–1190 (2015).
Dyusebaeva, M. A. et al. Antimicrobial activity of silver nanoparticles stabilized by liposoluble extract of artemisia terrae-albae. Processes 11, 3041 (2023).
Khatoon, N., Sharma, Y., Sardar, M. & Manzoor, N. Mode of action and anti-Candida activity of Artemisia annua mediated-synthesized silver nanoparticles. J. Medical Mycol. 29, 201–209 (2019).
Shaaban, M. T., Abdel-Hamid, M. S., Orabi, S. H., Korany, R. M. S. & Elbawab, R. H. Assessment of the antibacterial efficacy of silver nanoparticles-based Artemisia annua against methicillin-resistant Staphylococcus aureus-infected lung tissues in albino rats. J. Anal. Sci. Technol. 15, 25 (2024).
Lei, C., Wang, H., Liu, B. & Ye, H. Effects of silver nitrate on shoot regeneration of Artemisia annua L. Plant Biotechnol. 31, 71–75 (2014).
Saghirzadeh Darki, B., Shabani, L., Pourvaez, R. & Ghannadian, M. Effects of CuSO4 and AgNO3 on artemisinin and phenolic compound in shoot cultures of Artemisia annua L. Plant Process Funct. 8, 1–8 (2019).
Rani, D. & Vimolmangkang, S. Trends in the biotechnological production of isoflavonoids in plant cell suspension cultures. Phytochem. Rev. 21, 1843–1862 (2022).
Santoyo-Garcia, J. H. et al. Increased paclitaxel recovery from Taxus baccata vascular stem cells using novel in situ product recovery approaches. Bioresour. Bioprocess. 10, 68 (2023).
Yin, J.-Y. et al. Comprehensive strategies for paclitaxel production: insights from plant cell culture, endophytic microorganisms, and synthetic biology. Hortic. Res. 12, uhae346 (2025).
Efferth, T. Biotechnology applications of plant callus cultures. Engineering 5, 50–59 (2019).
Mosoh, D. A. Recent Advances in Phytochemical Research for Cancer Treatment. https://doi.org/10.5772/intechopen.1007200 (IntechOpen, 2024).
Mosoh, D. A. Widely-targeted in silico and in vitro evaluation of veratrum alkaloid analogs as FAK inhibitors and dual targeting of FAK and Hh/SMO pathways for cancer therapy: A critical analysis. Int. J. Biol. Macromol. 281, 136201 (2024).
Mosoh, D. A., Khandel, A. K., Verma, S. K. & Vendrame, W. A. Effects of sterilization methods and plant growth regulators on in vitro regeneration and tuberization in Gloriosa superba (L.). Vitro Cell. Dev. Biol- Plant 59, 792–807 (2023).
Mosoh, D. A., Khandel, A. K., Verma, S. K. & Vendrame, W. A. Optimizing callus induction and indirect organogenesis in non-dormant corm explants of Gloriosa superba (L.) via media priming. Front. Hortic. 3, 1378098 (2024).
Mosoh, D. A., Khandel, A. K., Verma, S. K. & Vendrame, W. A. Overcoming dual seed dormancy and enhancing in vitro seedling development of Gloriosa superba (L.) with a targeted sterilization approach and plant growth regulator synergy. Trop. Plants 3, e031 (2024).
Mosoh, D. A., Khandel, A. K., Verma, S. K. & Vendrame, W. A. Standardizing in vitro callus induction and indirect organogenesis from Gloriosa superba L. leaf explant (s) using exogenous phytohormones. J. Plant Biotechnol. 51, 237–252 (2024).
Mosoh, D. A. et al. Multi-explant and multiplex applications of plant growth regulators: a critical analysis of direct organogenesis in Gloriosa superba (L.). Trop. Plants 3, e039 (2024).
Mosoh, D. A., Prakash, O., Vendrame, W., Khandel, A. K. & Sharma, R. Preserving Earth’s flora in the 21 st century: climate, biodiversity, and global change factors (GCFs) since the mid-1940s. Front. Conserv. Sci. 5 (2024).
Kutschera, U. & Ray, P. M. Forever young: stem cell and plant regeneration one century after Haberlandt 1921. Protoplasma 259, 3–18 (2022).
Pant, M., Chankeshwara, N. N., Rathod, A. & Husen, A. Tissue Culture Techniques for Medicinal Plant Propagation. In Tissue Culture Techniques and Medicinal Plants 1–16 (CRC Press, 2024).
Ikeuchi, M., Sugimoto, K. & Iwase, A. Plant callus: mechanisms of induction and repression. Plant Cell 25, 3159–3173 (2013).
Ikeuchi M. et al. Wounding triggers callus formation via dynamic hormonal and transcriptional changes. Plant Physiol. 175, 1158–1174 (2017).
Lee, K. et al. ESR2–HDA6 complex negatively regulates auxin biosynthesis to delay callus initiation in Arabidopsis leaf explants during tissue culture. Plant Commun. 5, 100892 (2024).
Zhai, N. & Xu, L. Pluripotency acquisition in the middle cell layer of callus is required for organ regeneration. Nat. Plants 7, 1453–1460 (2021).
Zhang, G. et al. Cell wall remodeling promotes callus formation in poplar. Mol. Hortic. 4, 16 (2024).
Skoog, F. et al. Chemical regulations of growth and organ formation in plant tissue culture in vitro. Symp. Soc. Exp. Biol. 11, 118–131 (1957).
Mohammad, A. et al. Impact of plant growth regulators (PGRs) on callogenesis andartemisinin content in Artemisia annua L. plants. Ind. J. Biotechnol. 13, 26–33 (2014).
Martins, J. P. R. et al. Anatomy and photosystem II activity of in vitro grown Aechmea blanchetiana as affected by 1-naphthaleneacetic acid. Biol. Plant. 62, 211–221 (2018).
Gil, C. S., Jung, H. Y., Lee, C. & Eom, S. H. Blue light and NAA treatment significantly improve rooting on single leaf-bud cutting of Chrysanthemum via upregulated rooting-related genes. Sci. Hortic. 274, 109650 (2020).
Zhang, D. et al. Red and blue light promote the accumulation of artemisinin in Artemisia annua L. Molecules 23, 1329 (2018).
Pinto, A. Á. F. 2, 4-dichlorophenoxy acetic acid-mediated stress in tomato plants: a biochemical and molecular approach. Sci. Hortic. 321, 112214 (2016).
Song, Y. Insight into the mode of action of 2,4-dichlorophenoxyacetic acid (2,4-D) as an herbicide. J. Integr. Plant Biol. 56, 106–113 (2014).
Grossmann, K. Auxin herbicides: current status of mechanism and mode of action. Pest Manag. Sci. 66, 113–120 (2010).
Paniego, N. B. & Giulietti, A. M.Artemisia annua L.: dedifferentiated and differentiated cultures. Plant Cell Tissue Organ Cult. 36, 163–168 (1994).
Gopi, C. & Vatsala, T. In vitro studies on effects of plant growth regulators on callus and suspension culture biomass yield from Gymnema sylvestre R. Br. Afr. J. Biotechnol. 5, 395–398 (2006).
Chenshu, A., Wang, X., Yuan, X., Zhao, B. & Wang, Y. Optimization of cryopreservation of Artemisia annua L. callus. Biotechnol. Lett. 25, 35–38 (2003).
Roli Bartarya, R. B. et al. Larvicidal activity of Artemisia annua L. callus culture against Anopheles stephensi larvae. (2009).
Dangash, A. J., Pandya, N., Bharillya, A., Jhala, A. & Jain, D. Impact of exogenous elicitors on artemisinin production and trichome density in artemisia annua l. under subtropical conditions. Not. Sci. Biol. 6, 349–353 (2014).
Paulsamy, S. & Ganesan, C. Standardized protocol for the in vitro culture of Artemisia annua L.–a medicinal plant at high altitudes of Nilgiris, the Western Ghats. J. Res. Biol. 1, 173–178 (2011).
Tahir, S. M., Usman, I. S., Katung, M. D. & Ishiyaku, M. F. The effect of plant growth regulators on callus initiation in wormwood (Artemisia annua L.). Bayero J. Pure Appl. Sci. 9, 160–165 (2016).
Zebarjadi, A., Dianatkhah, S., Mohammadi, P. P. & Qaderi, A. Influence of abiotic elicitors on improvement production of artemisinin in cell culture of Artemisia annua L. Cell. Mol. Biol. 64, 1–5 (2018).
Keong, C. C., Nordin, F. A., Bhatt, A. & Keng, C. L. Culture MEDIUM AND VARIETAL SELECTION FOR ESTABLISHMENT OF CALLUS CULTUre of Artemisia annua. Educ. J. Sci. Math. Technol. 5, 47–56 (2018).
Campanoni, P. & Nick, P. Auxin-dependent cell division and cell elongation. 1-naphthaleneacetic acid and 2,4-dichlorophenoxyacetic acid activate different pathways. Plant Physiol. 137, 939–948 (2005).
Rahman, N. N. A., Rosli, R., Kadzimin, S. & Hakiman, M. Effects of auxin and cytokinin on callus induction in Catharanthus roseus (L.) G. Don. Fundam. Appl. Agric. 4, 928–932 (2019).
Jayaraman, S., Daud, N. H., Halis, R. & Mohamed, R. Effects of plant growth regulators, carbon sources and pH values on callus induction in Aquilaria malaccensis leaf explants and characteristics of the resultant calli. J. Res. 25, 535–540 (2014).
Rybin, D. A. et al. Characteristics of callus and cell suspension cultures of highbush blueberry (vaccinium corymbosum l.) cultivated in the presence of different concentrations of 2, 4-D and BAP in a nutrient medium. Plants 13, 3279 (2024).
Hemmati, N., Cheniany, M. & Ganjeali, A. Effect of plant growth regulators and explants on callus induction and study of antioxidant potentials and phenolic metabolites in Salvia tebesana Bunge. Bot. Serbica 44, 163–173 (2020).
Bano, A. S. et al. Callus induction, proliferation, enhanced secondary metabolites production and antioxidants activity of Salvia moorcroftiana L. as influenced by combinations of auxin, cytokinin and melatonin. Braz. Arch. Biol. Technol. 65, e22210200 (2022).
Chaâbani, G. et al. Effects of 2,4-dichlorophenoxyacetic acid combined to 6-Benzylaminopurine on callus induction, total phenolic and ascorbic acid production, and antioxidant activities in leaf tissue cultures of Crataegus azarolus L. var. aronia. Acta Physiol. Plant. 37, 16 (2015).
Munawarti, A., Nurhury, R. L., Arimarsetiowati, R., Prastowo, E. & Hakim, L. Induction and multiplication of callus of AS2K clones Coffea arabica L. through 2,4-D and BAP combination. IOP Conf. Ser. Earth Environ. Sci. 1356, 012035 (2024).
Al-Hamidi, A. O. A., Al-Hadedy, S. H. A. & Bashi, A. Z. A. K. Effect of 2,4-D and NAA in callus induction and differentiation from different explants of moringa oleifera lam. IOP Conf. Ser. Earth Environ. Sci. 1252, 012091 (2023).
Fazeli-Nasab, B. The effect of explant, BAP and 2, 4-D on callus induction of Trachyspermum ammi. Slovak J. Food Sci. 12, (2018).
Borjian, L. & Arak, H. A study on the effect of different concentration of plant hormones (BAP, NAA, 2, 4-D, and Kinetin) on callus induction in Brassica napus. Int. Res. J. Appl. Basic Sci. 5, 519–521 (2013).
Bibi, A., Khan, M., Adil, M. & Mashwani, Z. Production of callus biomass and antioxidant secondary metabolites in black cumin. JAPS J. Anim. Plant Sci. 28, 1321–1328 (2018).
Blando, F. et al. In vitro adventitious regeneration of Artemisia annua L. influencing artemisinin metabolism. Horticulturae 7, 438 (2021).
Jamaleddine, Z. O. et al. In vitro growth response of Artemisia annua seeds to different concentrations of plant growth regulators. Afr. J. Biotechnol. 10, 17841–17844 (2011).
Mirzaee, H., Sharafi, A. & Sohi, H. H. In vitro regeneration and transient expression of recombinant sesquiterpene cyclase (SQC) in Artemisia annua L. South. Afr. J. Bot. 104, 225–231 (2016).
Paul, S., Gupta, M. M. & Khanuja, S. P. S. Maintaining the artemisinin content through direct and indirect in vitro regeneration and their assessment of variations with the field grown mother plants of Artemisia annua L. Nat. Prod. Bioprospect.2, 194–199 (2012).
Gantait, S. & Mahanta, M. Hyperhydricity-induced changes among in vitro regenerants of gerbera. South Afr. J. Bot. 149, 496–501 (2022).
Ivanova, M. & Van Staden, J. Nitrogen source, concentration, and NH4+:NO3− ratio influence shoot regeneration and hyperhydricity in tissue cultured Aloe polyphylla. Plant Cell Tissue Organ Cult. PCTOC 99, 167–174 (2009).
Polivanova, O. B. & Bedarev, V. A. Hyperhydricity in plant tissue culture. Plants 11, 3313 (2022).
Pradhan, C., Routray, D. & Das, A. B. Silver nitrate mediated oxidative stress induced genotoxicity of allium cepa L. Cytologia 82, 183–191 (2017).
Ramadan, R. A. et al. effect of silver nitrate on in vitro regeneration and antioxidant responses of oilseed rape cultivars (brassica napus l.). J. Microbiol. Biotechnol. Food Sci. 10, e4494–e4494 (2021).
Adly, W. M. R. M. et al. Boosting polyamines to enhance shoot regeneration in potato (Solanum tuberosum L.) using AgNO3. Horticulturae 8, 113 (2022).
Ejaz, M. et al. Effect of silver nanoparticles and silver nitrate on growth of rice under biotic stress. IET Nanobiotechnol 12, 927–932 (2018).
Lam, V. P. et al. Effectiveness of silver nitrate application on plant growth and bioactive compounds in Agastache rugosa(Fisch. & C.A.Mey. kuntze. Heliyon 9, e20205 (2023).
Ahmad, M. et al. Transcriptomic and phenotypic responses of cucumber trichome density to silver nitrate and sodium thiosulfate application. Int. J. Mol. Sci. 26, 1298 (2025).
Husak, V., Kilchytska, U., Savchuk, Y. & Stambulska, U. The effect of silver nitrate on the biochemical parameters of Rosa canina L. J. Vasyl Stefanyk Precarpathian. Natl. Univ. Biol. 11, 57–65 (2024).
Shah, A. H. et al. Synergistic phytochemical and nanotechnological exploration of melia azedarach with silver nitrate: elucidating multifaceted antimicrobial, antioxidant, antidiabetic, and insecticidal potentials. Microsc. Res. Tech. 88, 542–554 (2025).
Mahood, H. E., Sarropoulou, V. & Tzatzani, T.-T. Effect of explant type (leaf, stem) and 2,4-D concentration on callus induction: influence of elicitor type (biotic, abiotic), elicitor concentration and elicitation time on biomass growth rate and costunolide biosynthesis in gazania (Gazania rigens) cell suspension cultures. Bioresour. Bioprocess. 9, 100 (2022).
de Morais Oliveira, J. P., Silva, A. J. da, Catrinck, M. N. & Clarindo, W. R. Embryonic abnormalities and genotoxicity induced by 2,4-dichlorophenoxyacetic acid during indirect somatic embryogenesis in Coffea. Sci. Rep. 13, 9689 (2023).
Baklouti, E. et al. 2,4-D induction of somaclonal variations in in vitro grown date palm (Phoenix dactylifera L. cv Barhee). Plant Cell Tissue Organ Cult.150, 191–205 (2022).
Morini, S., D’Onofrio, C., Bellocchi, G. & Fisichella, M. Effect of 2,4-D and light quality on callus production and differentiation from in vitro cultured quince leaves. Plant Cell Tissue Organ Cult. 63, 47–55 (2000).
Butova, V. V., Bauer, T. V., Polyakov, V. A., Rajput, V. D. & Minkina, T. M. Analyzing the benefits and limitations of advanced 2,4-D herbicide delivery systems. Crop Prot. 184, 106865 (2024).
Wei, Z. et al. Integrated physiological, hormonal and transcriptomic analyses reveal mechanisms of blackberry plants response to exogenous 6-benzylaminopurine. Sci. Hortic. 332, 113181 (2024).
Peredo, E. L., Ángeles, Revilla, M. & Arroyo-García, R. Assessment of genetic and epigenetic variation in hop plants regenerated from sequential subcultures of organogenic calli. J. Plant Physiol. 163, 1071–1079 (2006).
Us-Camas, R., Rivera-Solís, G., Duarte-Aké, F. & De-la-Peña, C. In vitro culture: an epigenetic challenge for plants. Plant CellTissue Organ Cult 118, 187–201 (2014).
Humbal, A. & Pathak, B. Influence of exogenous elicitors on the production of secondary metabolite in plants: a review (“VSI:secondary metabolites. Plant Stress 8, 100166 (2023).
Brown, G. D. The Biosynthesis of Artemisinin (Qinghaosu) and the Phytochemistry of Artemisia annua L. (Qinghao). Molecules 15, 7603–7698 (2010).
Li, J., Docile, H. J., Fisher, D., Pronyuk, K. & Zhao, L. Current status of malaria control and elimination in africa: epidemiology, diagnosis, treatment, progress and challenges. J. Epidemiol. Glob. Health 14, 561–579 (2024).
WHO. World malaria report 2023. https://www.who.int/teams/global-malaria-programme/reports/world-malaria-report-2023 (2023).
Milner, D. A. Malaria pathogenesis. Cold Spring Harb. Perspect. Med. 8, a025569 (2018).
Newton, C. R. J. C., Hien, T. T. & White, N. Cerebral malaria. J. Neurol. Neurosurg. Psychiatry 69, 433–441 (2000).
Phillips, R. E. & Solomon, T. Cerebral malaria in children. Lancet 336, 1355–1360 (1990).
Carson, J. et al. Overcoming insecticide resistance in Anopheles mosquitoes by using faster-acting solid forms of deltamethrin. Malar. J. 22, 129 (2023).
Guyatt, H. L. & Snow, R. W. Impact of Malaria during pregnancy on low birth weight in Sub-Saharan Africa. Clin. Microbiol. Rev. 17, 760–769 (2004).
Macarayan, E., Papanicolas, I. & Jha, A. The quality of malaria care in 25 low-income and middle-income countries. BMJ Glob. Health 5, e002023 (2020).
Nakweya, G. Malaria: African leaders pledge to tackle funding gap amid uncertainty over foreign aid. BMJ 388, r271 (2025).
Paaijmans, K. P. & Lobo, N. F. Gaps in protection: the actual challenge in malaria elimination. Malar. J. 22, 46 (2023).
Rannan-Eliya, R. P. Financing malaria. PLOS Glob. Public Health 2, e0000609 (2022).
Schreidah, C. et al. Expansion of artemisinin partial resistance mutations and lack of histidine rich protein-2 and -3 deletions in Plasmodium falciparum infections from Rukara, Rwanda. Malar. J. 23, 150 (2024).
Rai, R. et al. UV-B and UV-C pre-treatments induce physiological changes and artemisinin biosynthesis in Artemisia annua L. – an antimalarial plant. J. Photochem. Photobiol. B. 105, 216–225 (2011).
Judd, R. et al. Artemisinin biosynthesis in non-glandular trichome cells of Artemisia annua. Mol. Plant 12, 704–714 (2019).
Phillips, R., Kaeppler, S. & Peschke, V. Do we understand somaclonal variation? In: Nijkamp, H.J.J., Van Der Plas, L.H.W., Van Aartrijk, J. (eds) Progress in Plant Cellular and Molecular Biology. Current Plant Science and Biotechnology in Agriculture, vol 9. (Springer, 1990).
Skirvin, R. M., McPheeters, K. D. & Norton, M. Sources and frequency of somaclonal variation. HortScience 29, 1232–1237 (1994).
Wang, Q.-M. & Wang, L. An evolutionary view of plant tissue culture: somaclonal variation and selection. Plant Cell Rep. 31, 1535–1547 (2012).
Das, S. et al. From induction to innovation: investigating somaclonal variation induced by tissue culture and its role in advancing fruit crop improvement. Plant Cell Tissue Organ Cult.161, 25 (2025).
Manchanda, P., Sharma, D., Kaur, G., Kaur, H., & Vanshika. Exploring the significance of somaclonal variations in horticultural crops. Mol. Biotechnol. 67, 2185–2203 (2024).
Pawełkowicz, M. E., Skarzyńska, A., Mróz, T., Bystrzycki, E. & Pląder, W. Molecular insight into somaclonal variation phenomena from transcriptome profiling of cucumber (Cucumis sativus L.) lines. Plant Cell Tissue Organ Cult. PCTOC 145, 239–259 (2021).
Keng, C. L., Singaram, L. & Lim, B. P. Production of artemisinin from cell suspension culture of Artemisia annua L. In ProceedingsAsia Pacific Conference on Plant Tissue and Agribiotechnology, vol. 17, p. 21. (APaCPA, 2007).
Karuppanapandian, T. et al. 2,4-dichlorophenoxyacetic acid-induced leaf senescence in mung bean (Vigna radiata L. Wilczek) and senescence inhibition by co-treatment with silver nanoparticles. Plant Physiol. Biochem. 49, 168–177 (2011).
Khan, S., Alvi, A. F., Saify, S., Iqbal, N. & Khan, N. A. The ethylene biosynthetic enzymes, 1-aminocyclopropane-1-carboxylate (ACC) synthase (ACS) and ACC oxidase (ACO): the less explored players in abiotic stress tolerance. Biomolecules 14, 90 (2024).
Pattyn, J., Vaughan-Hirsch, J. & Van de Poel, B. The regulation of ethylene biosynthesis: a complex multilevel control circuitry. N. Phytol. 229, 770–782 (2021).
Abel, S., Nguyen, M. D., Chow, W. & Theologis, A. ASC4, a Primary Indoleacetic Acid-responsive Gene Encoding 1-Aminocyclopropane-1-carboxylate synthase in Arabidopsis thaliana. J. Biol. Chem. 270, 19093–19099 (1995).
Yue, P. et al. Auxin-activated MdARF5 induces the expression of ethylene biosynthetic genes to initiate apple fruit ripening. N. Phytol. 226, 1781–1795 (2020).
Imani, S. et al. Current innovations in mRNA vaccines for targeting multidrug-resistant ESKAPE pathogens. Biotechnol. Adv. 79, 108492 (2025).
Miller, W. R. & Arias, C. A. ESKAPE pathogens: antimicrobial resistance, epidemiology, clinical impact and therapeutics. Nat. Rev. Microbiol. 22, 598–616 (2024).
WHO. WHO fungal priority pathogens list to guide research, development and public health action. https://www.who.int/publications/i/item/9789240060241 (2022).
WHO. WHO bacterial priority pathogens list, 2024: bacterial pathogens of public health importance to guide research, development and strategies to prevent and control antimicrobial resistance. https://www.who.int/publications/i/item/9789240093461 (2024).
Golbarg, H. & Mehdipour Moghaddam, M. J. Antibacterial potency of medicinal plants including artemisia annua and oxalis corniculata against multi-drug resistance E. coil. BioMed. Res. Int. 2021, 9981915 (2021).
Pang, Z., Raudonis, R., Glick, B. R., Lin, T.-J. & Cheng, Z. Antibiotic resistance in Pseudomonas aeruginosa: mechanisms and alternative therapeutic strategies. Biotechnol. Adv. 37, 177–192 (2019).
Qin, S. et al. Pseudomonas aeruginosa: pathogenesis, virulence factors, antibiotic resistance, interaction with host, technology advances and emerging therapeutics. Signal Transduct. Target. Ther. 7, 199 (2022).
Ahameethunisa, A. R. & Hopper, W. Antibacterial activity of Artemisia nilagirica leaf extracts against clinical and phytopathogenic bacteria. BMC Complement. Altern. Med. 10, 6 (2010).
Ahameethunisa, A. R. & Hopper, W. In vitro antimicrobial activity on clinical microbial strains and antioxidant properties of Artemisia parviflora. Ann. Clin. Microbiol. Antimicrob. 11, 30 (2012).
Ahuja, A., Yi, Y.-S., Kim, M.-Y. & Cho, J. Y. Ethnopharmacological properties of Artemisia asiatica: a comprehensive review. J. Ethnopharmacol. 220, 117–128 (2018).
Karabegović, I. et al. Comparison of antioxidant and antimicrobial activities of methanolic extracts of the artemisia sp. recovered by different extraction techniques. Chin. J. Chem. Eng. 19, 504–511 (2011).
Mamatova, A. S. et al. Phytochemical composition of wormwood (Artemisia gmelinii) extracts in respect of their antimicrobial activity. BMC Complement. Altern. Med. 19, 288 (2019).
Govindaraju, M., Chikkamadaiah, M., Mahadevamurthy, M., Mylari, M. H. & Singh, S. M. S. Evaluation of phytochemicals and antibacterial activity of leaf and leaf derived callus extracts of Artemisia annua L. and Sauropus androgynus (L.) Merr. J. Appl. Nat. Sci. 8, 2189 (2016).
Ćavar, S., Maksimović, M., Vidic, D. & Parić, A. Chemical composition and antioxidant and antimicrobial activity of essential oil of Artemisia annua L. from Bosnia. Ind. Crops Prod. 37, 479–485 (2012).
Parameswari, P., Devika, R. & Vijayaraghavan, P. In vitro anti-inflammatory and antimicrobial potential of leaf extract from Artemisia nilagirica (Clarke) Pamp. Saudi J. Biol. Sci. 26, 460–463 (2019).
ROOFIGARI, I. M., Doudi, M. & Rezayatmand, Z. Anticandidal effects of aqueous and callus extracts of Artemisia aucheri 4, 389 (2014).
Appalasamy, S. et al. Antimicrobial activity of artemisinin and precursor derived from in vitro plantlets of Artemisia annua L. BioMed. Res. Int. 2014, 215872 (2014).
Donato, R., Santomauro, F., Bilia, A. R., Flamini, G. & Sacco, C. Antibacterial activity of Tuscan Artemisia annua essential oil and its major components against some foodborne pathogens. LWT Food Sci. Technol. 64, 1251–1254 (2015).
Gupta, P. C., Dutta, B., Pant, D., Joshi, P. & Lohar, D. In vitro antibacterial activity of Artemisia annua Linn. growing in India. Int. J. Green Pharm. IJGP 3, 3 (2009).
Hameed, I. H., Altameme, H. J. & Idan, S. A. Artemisia annua: Biochemical products analysis of methanolic aerial parts extract and anti-microbial capacity. Res. J. Pharm. Biol. Chem. Sci. 7, 1843–1868 (2016).
Juteau, F., Masotti, V., Bessiere, J. M., Dherbomez, M. & Viano, J. Antibacterial and antioxidant activities of Artemisia annua essential oil. Fitoterapia 73, 532–535 (2002).
Kim, W.-S. et al. Anti-inflammatory, antioxidant and antimicrobial effects of artemisinin extracts from Artemisia annua L. Korean J. Physiol. Pharmacol. 19, 21–27 (2015).
Massiha, A., Khoshkholgh-Pahlaviani, M. M., Issazadeh, K., Bidarigh, S. & Zarrabi, S. Antibacterial activity of essential oils and plant extracts of Artemisia (Artemisia annua L.) in vitro. Zahedan J. Res. Med. Sci. 15, 14–18 (2013).
Raj, T., Kumar, P., Rathee, R. & Dubey, K. Screening of some medicinal plants for their antimicrobial activities. Int. J. Pharm. Pharm. Sci. 8, 202–206 (2016).
Rolta, R., Sharma, A., Sourirajan, A., Mallikarjunan, P. K. & Dev, K. Combination between antibacterial and antifungal antibiotics with phytocompounds of Artemisia annua L: a strategy to control drug resistance pathogens. J. Ethnopharmacol. 266, 113420 (2021).
Tajehmiri, A., Issapour, F., Moslem, M. N., Lakeh, M. T. & Kolavani, M. H. In vitro antimicrobial activity of Artemisia annua leaf extracts against pathogenic bacteria. Adv. Stud. Biol. 6, 93–97 (2014).
Ceballos-Garzon, A., Holzapfel, M., Welsch, J. & Mercer, D. Identification and antifungal susceptibility patterns of reference yeast strains to novel and conventional agents: a comparative study using CLSI, EUCAST and Sensititre YeastOne methods. JAC Antimicrob. Resist. 7, dlaf040 (2025).
Gaur, P. et al. Interpretation of antimicrobial susceptibility testing using european committee on antimicrobial susceptibility testing (EUCAST) and clinical and laboratory standards institute (CLSI) breakpoints: analysis of agreement. Cureus 15, e36977 (2023).
Giske, C. G., Turnidge, J., Cantón, R. & Kahlmeter, G. on behalf of the EUCAST steering committee. update from the european committee on antimicrobial susceptibility testing (EUCAST). J. Clin. Microbiol. 60, e00276–21 (2022).
Kahlmeter, G., Giske, C. G., Kirn, T. J. & Sharp, S. E. Point-counterpoint: differences between the european committee on antimicrobial susceptibility testing and clinical and laboratory standards institute recommendations for reporting antimicrobial susceptibility results. J. Clin. Microbiol. 57, e01129-19.
Karakonstantis, S., Rousaki, M., Vassilopoulou, L. & Kritsotakis, E. I. Global prevalence of cefiderocol non-susceptibility in Enterobacterales, Pseudomonas aeruginosa, Acinetobacter baumannii, and Stenotrophomonas maltophilia: a systematic review and meta-analysis. Clin. Microbiol. Infect. 30, 178–188 (2024).
Suravaram, S., Hada, V. & Ahmed Siddiqui, I. Comparison of antimicrobial susceptibility interpretation among Enterobacteriaceae using CLSI and EUCAST breakpoints. Indian J. Med. Microbiol. 39, 315–319 (2021).
Zhao, J., Davis, L. C. & Verpoorte, R. Elicitor signal transduction leading to production of plant secondary metabolites. Biotechnol. Adv. 23, 283–333 (2005).
Prasad, B. Phthalate pollution: environmental fate and cumulative human exposure index using the multivariate analysis approach. Environ. Sci. Process. Impacts 23, 389–399 (2021).
Renwick, M. J. et al. Management of phthalates in Canada and beyond: can we do better to protect human health? Front. Public Health 12, 1473222 (2024).
Trivedi, P. et al. Analysis of composition, morphology, and biosynthesis of cuticular wax in wild type bilberry (Vaccinium myrtillus L.) and its glossy mutant. Food Chem. 354, 129517 (2021).
Šola, I., Gmižić, D., Pinterić, M., Tot, A. & Ludwig-Müller, J. Adjustments of the phytochemical profile of broccoli to low and high growing temperatures: implications for the bioactivity of its extracts. Int. J. Mol. Sci. 25, 3677 (2024).
Ciriello, M. et al. Salt-induced stress impacts the phytochemical composition and aromatic profile of three types of basil in a genotype-dependent mode. Plants 12, 2167 (2023).
Mandal, M. et al. Reactive oxygen species (ROS) and reactive nitrogen species (RNS) in plants– maintenance of structural individuality and functional blend. Adv. Redox Res. 5, 100039 (2022).
Wang, J., Zhang, H. & Allen, R. D. Overexpression of an arabidopsis peroxisomal ascorbate peroxidase gene in tobacco increases protection against oxidative stress1. Plant Cell Physiol. 40, 725–732 (1999).
Schmitt, F.-J. et al. Reactive oxygen species: re-evaluation of generation, monitoring and role in stress-signaling in phototrophic organisms. Biochim. Biophys. Acta Bioenerg. 1837, 835–848 (2014).
Anjum, N, Umar, S. & Chan, M.T. Ascorbate-Glutathione Pathway and Stress Tolerance in Plants. (Springer Netherlands, Dordrecht, 2010).
Panda, D. & Barik, J. Flooding tolerance in rice: focus on mechanisms and approaches. Rice Sci. 28, 43–57 (2021).
Mir, R. A. & Khah, M. A. Chapter 10 - Recent progress in enzymatic antioxidant defense system in plants against different environmental stresses. in Improving Stress Resilience in Plants (eds. Ahanger, M. A., Bhat, J. A., Ahmad, P. & John, R.) 203–224 (Academic Press, 2024).
Haider, M. S., Jaskani, M. J. & Fang, J. Overproduction of ROS: underlying molecular mechanism of scavenging and redox signaling. In Biocontrol Agents and Secondary Metabolites (ed. Jogaiah, S.) 347–382 (Woodhead Publishing, 2021).
Kumar, P. Measurement of ascorbate peroxidase activity in sorghum. Bio-Protoc. 12, e4531 (2022).
Pandey, S. et al. Abiotic stress tolerance in plants: myriad roles of ascorbate peroxidase. Front. Plant Sci. 8, 581 (2017).
Wang, J. et al. Overexpression of CaAPX induces orchestrated reactive oxygen scavenging and enhances cold and heat tolerances in tobacco. BioMed. Res. Int. 2017, 4049534 (2017).
Li, H.-B. et al. A cotton ascorbate peroxidase is involved in hydrogen peroxide homeostasis during fibre cell development. N. Phytol. 175, 462–471 (2007).
Akilan, S. et al. Evaluation of osmotic stress tolerance in transgenic Arabidopsis plants expressing Solanum tuberosum D200 gene. J. Plant Interact. 14, 79–86 (2019).
Giustarini, D. et al. Pitfalls in the analysis of the physiological antioxidant glutathione (GSH) and its disulfide (GSSG) in biological samples: an elephant in the room. J. Chromatogr. B 1019, 21–28 (2016).
You, S.-M., Jeong, K.-B., Kang, D.-G., Kim, S.-M. & Kim, Y.-R. Label-free detection of glutathione and glutathione disulfide in biological fluid by using an alpha-hederin nanopore. Biosens. Bioelectron. 262, 116559 (2024).
Tsiasioti, A. & Tzanavaras, P. D. Determination of glutathione and glutathione disulfide using liquid chromatography: a review on recent applications. Microchem. J. 193, 109157 (2023).
Sameena, P. P. et al. 6-benzylaminopurine alleviates the impact of Cu2+ toxicity on photosynthetic performance of Ricinus communis L. seedlings. Int. J. Mol. Sci. 22, 13349 (2021).
Zayova, E. et al. Tissue culture applications of Artemisia annua L. Callus for indirect organogenesis and production phytochemical. Plant Tissue Cult. Biotechnol. 30, 97–106 (2020).
Thao, N. P. et al. Role of ethylene and its cross talk with other signaling molecules in plant responses to heavy metal stress. Plant Physiol. 169, 73–84 (2015).
Erdemoğlu, N., Orhan, İ, Kartal, M., Adıgüzel, N. & Bani, B. Determination of artemisinin in selected artemisia l. species of turkey by reversed phase HPLC. Rec. Nat. Prod. 1, 36–43 (2007).
Jankowski, A. M., Vardar, C., Talarico, M. V., Wuchte, L. & Byrne, M. E. Methodology for high-performance liquid chromatography detection of latanoprost and latanoprost free acid. Acta Chromatogr. 37, 67–75 (2024)
ICHHT Guideline. Validation of analytical procedures: text and methodology. Q2 R1 1, 05 (2005).
CLSI. Methods for Antimicrobial Susceptibility Testing of Anaerobic Bacteria. (Clinical and Laboratory Standards Institute Pennsylvania (USA, 2018).
Elavarthi, S. & Martin, B. Spectrophotometric assays for antioxidant enzymes in plants. Plant Stress Toler. Methods Protoc. 639, 273–280 (2010).
Nakano, Y. & Asada, K. Hydrogen peroxide is scavenged by ascorbate-specific peroxidase in spinach chloroplasts. Plant Cell Physiol. 22, 867–880 (1981).
Mansoor, S. et al. Reactive oxygen species in plants: from source to sink. Antioxidants 11, 225 (2022).
Gechev, T. S. & Hille, J. Hydrogen peroxide as a signal controlling plant programmed cell death. J. Cell Biol. 168, 17–20 (2005).
Acknowledgements
This study did not receive any external funding. The corresponding author extends his deepest gratitude to Chief MOSOH Paul Tandong and Chieftess Ateyim Espe MOSOH Ostensia Nkeng of PINYIN (Santa, North-West Region, Cameroon) for their unwavering support, which has been instrumental to his professional growth and this research endeavor. The corresponding author wishes to express profound gratitude to Dr. D.C. Jain (SAGE University, Indore), a distinguished expert on Artemisia annua L. in India, for the formative mentorship that significantly shaped the author’s approach to this research. Their enlightening dialogues, initiated after an online workshop on plant tissue culture and continued through valuable in-person meetings, offered critical perspectives on the species’ cultivation, industrial extraction, and commercialization. The knowledge imparted during these interactions, rooted in Dr. Jain’s four decades of experience, provided an essential intellectual framework that indirectly yet powerfully guided the development of this project. The corresponding author also gratefully acknowledges Dr. Ashok Kumar Khandel (CEO, Bhoomi Institute of Research in Advanced Biotechnology, Bhopal, MP, India) for his expert guidance in plant tissue culture. Their joint work on Gloriosa superba L. led to several high-impact peer reviewed publications, and the methodologies and insights gained continue to inform this research. Sincere thanks are extended to Dr. Sandeep Verma (SAGE University, Indore) for his warm hospitality and collaborative support during visits to his department. Our work together culminated in research publications on G. superba co-authored with Dr. Ashok, and we gratefully acknowledge his direct scholarly contribution to that work. The corresponding author expresses special appreciation to Mr. Sujeet Singh and Mrs. Madhulika Singh for their invaluable support during critical stages of the project, including sample extraction, instrumental analysis, and microbial experiments. All required laboratory services were provided under favorably negotiated financial terms. The corresponding author is especially grateful for their generosity in facilitating laboratory access and for their support in arranging accommodation (at Mr. Ajay Kumar’s residence) in Lucknow and daily commuting to and from Cytogene Lab, which ensured a smooth and productive research stay. He also acknowledges the dedicated staff at their lab for their technical assistance and routine support, which were essential to the project’s success. Furthermore, the corresponding author extends his sincere appreciation to all individuals and organizations whose support were instrumental to this research. He is particularly grateful to the founder of a prominent biodiversity research institution in India for his support during the initial phase of the study. The corresponding author also thanks the founder of a leading plant tissue culture (PTC) laboratory in Jabalpur, India, for generously providing laboratory services, technical resources, and expert assistance under favorably negotiated financial terms. The skilled personnel at the PTC laboratory are acknowledged with deep respect for their support at the initial stages of this work. Finally, the corresponding author expresses his profound appreciation to all reviewers, collaborators, mentors, and institutions whose direct or indirect support enriched this study.
Author information
Authors and Affiliations
Contributions
D.M. conceptualized the study, acquired the funding, and provided overall project administration and supervision. D.M. developed the methodology, conducted the investigation, performed the formal analysis, curated the data, and created the visualizations. As the principal investigator, D.M. was responsible for writing the manuscript, including the original draft and all subsequent reviews and edits. W.V. contributed to project administration and assisted in writing by reviewing and editing the manuscript. All authors read and approved the final manuscript.
Corresponding author
Ethics declarations
Competing interests
The authors declare no competing interests.
Additional information
Publisher’s note Springer Nature remains neutral with regard to jurisdictional claims in published maps and institutional affiliations.
Supplementary information
Rights and permissions
Open Access This article is licensed under a Creative Commons Attribution-NonCommercial-NoDerivatives 4.0 International License, which permits any non-commercial use, sharing, distribution and reproduction in any medium or format, as long as you give appropriate credit to the original author(s) and the source, provide a link to the Creative Commons licence, and indicate if you modified the licensed material. You do not have permission under this licence to share adapted material derived from this article or parts of it. The images or other third party material in this article are included in the article’s Creative Commons licence, unless indicated otherwise in a credit line to the material. If material is not included in the article’s Creative Commons licence and your intended use is not permitted by statutory regulation or exceeds the permitted use, you will need to obtain permission directly from the copyright holder. To view a copy of this licence, visit http://creativecommons.org/licenses/by-nc-nd/4.0/.
About this article
Cite this article
Mosoh, D.A., Vendrame, W.A. Engineered elicitation in Artemisia annua L. callus cultures alters artemisinin biosynthesis, antioxidant responses, and bioactivity. npj Sci. Plants 1, 10 (2025). https://doi.org/10.1038/s44383-025-00009-1
Received:
Accepted:
Published:
Version of record:
DOI: https://doi.org/10.1038/s44383-025-00009-1